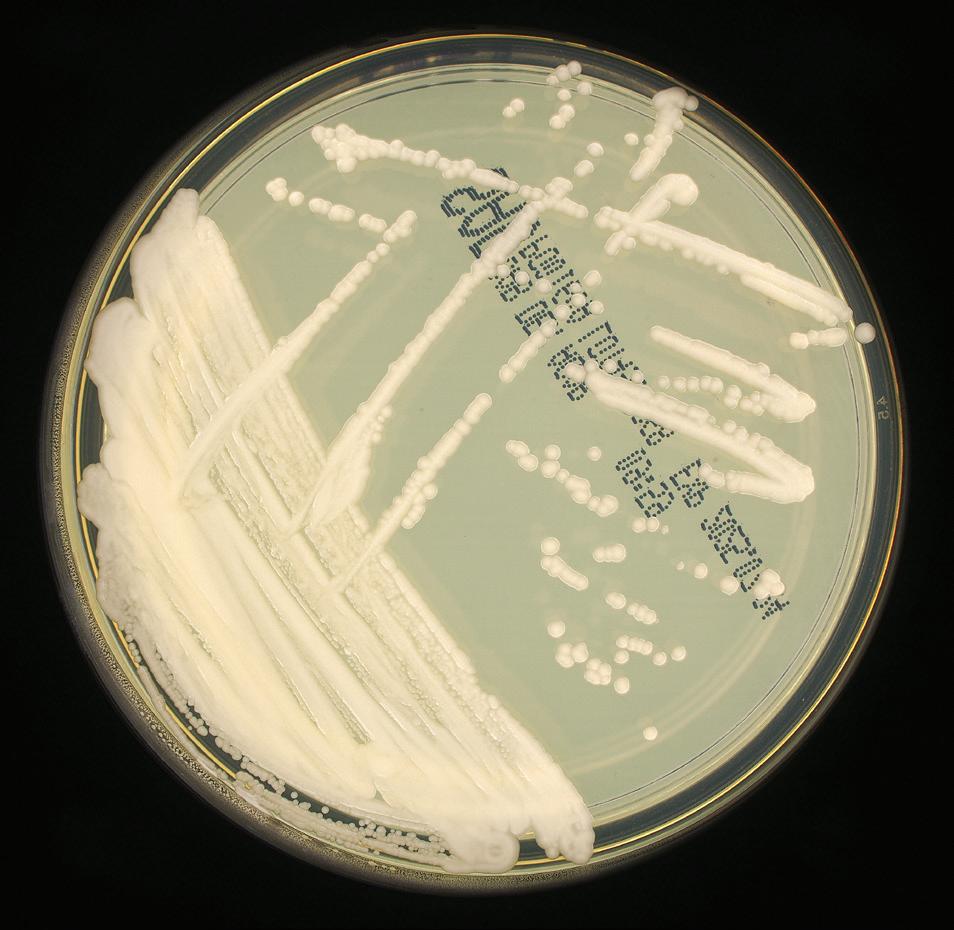

The Peer-Authored Management Source for Lab Professionals since 1969






![]()


The Peer-Authored Management Source for Lab Professionals since 1969










Directly load tube









RespDirect® Collection Kit
NO
Uncapping
NO Specimen Transfer
Inactivates Pathogens













Aptima® SARS-CoV-2 Assay Panther Fusion®
SARS-CoV-2/Flu A/B/RSV Assay NP and Nasal Samples















































































































































































































































Expedite your respiratory testing workflow with the RespDirect® Collection Kit that loads directly on the Panther® system.







Load and go alongside specimen types for other assays with true random and continuous access.



Reduce human error and repetitive motion injuries
Inactivates common respiratory pathogens
Guanidine free, nontoxic media
One collection kit for nasal and NP swabs
Penetrable cap serves as additional crosscontamination barrier





















Penetrable cap eliminates manual uncapping, recapping and specimen transfer.




References


Prime Plus provides the most clinical value of any blood gas/critical care analyzer by adding essential tests for kidney function (BUN, Creatinine, eGFR), plasma volume (ePV), ionized magnesium (iMg) and MCHC.
Hypomagnesemia is a frequent finding in critically ill patients.1 Magnesium therapy guided by real time ionized magnesium monitoring has been shown to improve outcome in these patients. 2
Over 50% of patients admitted to the ICU develop some degree of acute kidney injury. 3 Creatinine, eGFR, and BUN monitoring provides indication of changes in kidney function and helps guide therapy to prevent AKI.
The plasma volume status of a patient is one of the top priorities in evaluating and treating critical illness including CHF, ARDS, AKI, and Sepsis.4-6
Helps differentiate types of anemia.
novabiomedical.com
1. Soliman HM. Development of ionized hypomagnesemia is associated with higher mortality rates. Crit Care Med 2003;31(4):1082-7.
2. Wilkes NJ et al. Correction of ionized plasma magnesium during cardiopulmonary bypass reduces the risk of postoperative cardiac arrhythmia. Anesth and Analg 2002;95(4) 828-834.
3. Mandelbaum T et al. Outcome of critically ill patients with acute kidney injury using the AKIN criteria. Crit Care Med 2011;39(12):2659-2664.

4. Kobayashi M et al. Prognostic Value of Estimated Plasma Volume in Heart Failure in Three Cohort Studies; Clin Res Cardiol 2019;108(5): 549-561.
5. Niedermeyer, et al. Calculated Plasma Volume Status Is Associated With Mortality in Acute Respiratory Distress Syndrome. Critical Care Explorations: September 2021, V3(9):1-9.
6. Kim HK et al. Prognostic Value of Estimated Plasma Volume Status in Patients with Sepsis. J Korea Med Sci 2020;9(37):1-10.





























































































Hemostasis Solutions by Sysmex
The right hemostasis solution for your lab is more than just an analyzer--it’s the winning combination of advanced technology and reagents, proven reliability and best-in-class service. Partnering with Sysmex gives you all of that and more, allowing you to clot smarter, not harder.
www.sysmex.com/us


































For 25 consecutive years Sysmex has rated highest for System Reliability & Service.*


















the bench: How artificial intelligence is redefining respiratory pathogen diagnostics in the clinical laboratory By Stephen Bishop, MBA, MS, CLS, MLS(ASCP)CM, CPHQ CLINICAL
Preparing your lab’s automation infrastructure for the inclusion of digital pathology and AI By
Lisa-Jean Clifford
The (r)evolution of ESR: Photometric rheology By Richa Bedi, PhD, MHA, MS, MLT(ASCP); Carrie V. Vause, MS; and Jane M. Caldwell, PhD
Dimmer
MLO’s 2025 survey of medical laboratory professionals: Record participation reveals a profession at a crossroads: Passionate, committed—and under pressure By Kara Nadeau
corner By Patty J. Eschliman, MHA, MLS(ASCP), DLM, CPC
By Robert F. Moran, PhD, FCCM, FIUPAC
By Allyson J. Kozak, PhD, MBA, NRCC
Your patients deserve sexual health testing they can trust. Roche's assays are designed with layers of protection, ensuring accuracy, delivering stability and minimizing false negative and false positive results. We provide dependable results on every test, every time.
http://go.roche.com/STI

Vol. 57, No. 8

By Christina Wichmann
Editor in Chief
In July, MLO staff attended the annual meeting for the Association for Diagnostics and Laboratory Medicine (ADLM) in Chicago. I would love to share some of the information with you — I attended two sessions pertaining to diagnostic stewardship. Some important takeaways from these sessions:
• Diagnosis of illness should be made with tests, and the illness should be identified and treated by diagnostic test results. One speaker pointed out that disease diagnosis does not have anything like the longstanding surgical checklist and pause.
• Goals for improving patient diagnoses include facilitating more effective teamwork in the diagnostic process among healthcare professionals, patients, and their families. Enhancing healthcare professionals’ education and training in the diagnostic process. Developing and deploying approaches to identify, learn from, and reduce diagnostic errors and near misses. Developing a reporting environment and learning system that facilitates improved diagnosis. Designing a payment and care delivery environment that supports the diagnostic process.
• A key challenge facing laboratories is helping patients and providers navigate increased test availability. Having a system where these requests can be handled systematically is very important. For new test requests, a multidisciplinary team and laboratory should evaluate these requests by reviewing current literature, clinical practice guidelines, and comparable in-house tests, and then determine whether testing would be reimbursed.
I attended a press event hosted by Danaher Diagnostics (its major operating company is Beckman Coulter). The panelists talked about the company’s goal of bringing precision care (timely, highly accurate, accessible diagnostics) to the general public…in our hospitals, not just in large academia. “Accessible diagnostics” is defined as:
• Accurate and clinically meaningful by using sensitive biomarker assays and AI- enhanced algorithms to inform early intervention and therapy selection.
• Scalable and affordable high-throughput systems, standardized reagents, and integrated lab deployment to reduce per-test cost and complexity.
• Available across diverse settings, including small labs and large health systems alike.
• Minimally invasive and user-friendly with automated workflows to ease adoption.
I also attended Siemens Healthineers’ press conference that summarized a survey of 408 U.S. physicians. Separately, a survey of 1,000 U.S. patients, qualified by having had laboratory testing done within the past two years, was conducted during the same time frame to obtain the patient perspective. Noteworthy results of the surveys indicated the following:
• 98% of physicians have modified a diagnosis or treatment plan based on lab test results.
• 98% of physicians agree lab results help them justify their clinical course of action.
• 99% of physicians agree clinical lab testing is an integral part of the healthcare system.
• 93% of patients expect their doctor to order testing of interest to them upon their request.
• 87% of patients trust their doctor’s recommendation if they advise against a test the patient requests.
I welcome your comments and questions — please send them to me at cwichmann@mlo-online.com.
EDITOR IN CHIEF Christina Wichmann cwichmann@mlo-online.com
MANAGING EDITOR Erin Brady ebrady@endeavorb2b.com
PRODUCTION MANAGER Edward Bartlett
ART DIRECTOR Kelli Mylchreest
AUDIENCE DEVELOPMENT/LIST RENTALS Laura Moulton | lmoulton@endeavorb2b.com
ADVERTISING SERVICES MANAGER Karen Runion | krunion@endeavorb2b.com
ADVERTISING
SALES DIRECTOR OF MEDICAL & HEALTHCARE TECHNOLOGY/DENTAL Brian Rosebrook DIRECTOR OF SALES
EAST COAST/MIDWEST SALES, CLASSIFIEDS Carol Vovcsko (941) 321-2873 | cvovcsko@mlo-online.com
SOUTH/WEST COAST/ILLINOIS SALES Lora Harrell (941) 328-3707 | lharrell@mlo-online.com
MLO EDITORIAL ADVISORY BOARD
John Brunstein, PhD, Biochemistry (Molecular Virology) President & CSO PathoID, Inc., British Columbia, Canada
Lisa-Jean Clifford, COO & Chief Strategy Officer Gestalt, Spokane, WA
Barbara Strain, MA, SM(ASCP), CVAHP Principal, Barbara Strain Consulting LLC, Formerly Director, Value Management, University of Virginia Health System, Charlottesville, VA
Jeffrey D. Klausner, MD, MPH Professor of Preventive Medicine in the Division of Disease Prevention, Policy and Global Health, Department of Preventive Medicine at University of Southern California Keck School of Medicine. Donna Beasley, DLM(ASCP), Director Huron Healthcare, Chicago, IL
Anthony Kurec, MS, H(ASCP)DLM, Clinical Associate Professor, Emeritus SUNY Upstate Medical University, Syracuse, NY
Suzanne Butch, MLS(ASCP)CM, SBBCM, DLMCM Freelance Consultant, Avon, OH
Paul R. Eden, Jr., MT(ASCP), PhD, Lt. Col., USAF (ret.) (formerly) Chief, Laboratory Services, 88th Diagnostics/Therapeutics Squadron, Wright-Patterson AFB, OH
Daniel J. Scungio, MT (ASCP), SLS, CQA (ASQ), Consultant at Dan the Lab Safety Man and Safety Officer at Sentara Healthcare, Norfolk, VA CORPORATE TEAM
CEO Chris Ferrell COO Patrick Rains CRO Paul Andrews CDO Jacquie Niemiec CALO Tracy Kane CMO Amanda Landsaw EVP INFRASTRUCTURE & PUBLIC SECTOR GROUP Kylie Hirko
VP OF CONTENT STRATEGY, INFRASTRUCTURE & PUBLIC SECTOR GROUP Michelle Kopier 30 Burton Hills Blvd., Suite 185 Nashville, TN 37215 800-547-7377 | www.mlo-online.com
Medical Laboratory Observer USPS Permit 60930, ISSN 0580-7247 print, ISSN 2771-6759 online is published 10 times annually (Jan, Mar, Apr, May, Jul, Aug, Aug-CLR, Sep, Oct, Nov) by Endeavor Business Media, LLC. 201 N Main St 5th Floor, Fort Atkinson, WI 53538. Periodicals postage paid at Fort Atkinson, WI, and additional mailing offices. POSTMASTER: Send address changes to Medical Laboratory Observer, PO Box 3257, Northbrook, IL 60065-3257. SUBSCRIPTIONS: Publisher reserves the right to reject non-qualified subscriptions. Subscription prices: U.S. $160.00 per year; Canada/Mexico $193.75 per year; All other countries $276.25 per year. All subscriptions are payable in U.S. funds. Send subscription inquiries to Medical Laboratory Observer, PO Box 3257, Northbrook, IL 60065-3257. Customer service can be reached toll-free at 877-382-9187 or at MLO@ omeda.com for magazine subscription assistance or questions. Printed in the USA. Copyright 2025 Endeavor Business Media, LLC. All rights reserved. No part of this publication may be reproduced or transmitted in any form or by any means, electronic or mechanical, including photocopies, recordings, or any information storage or retrieval system without permission from the publisher. Endeavor Business Media, LLC does not assume and hereby disclaims any liability to

















Smart transfer system allows for a compact footprint: The AUTION EYE connects with the AUTION MAX AX-4060, and results in a very small footprint (41.9" x 25.6" x 23.6").
Automatic Dilution Function
Atlas Image Collection
Microscopic Automatic Image Collection
Compact Footprint
Automatic Cross-check Function
Gating Function

Vanta survey finds most HIPAA violations come from employee error
More HIPAA violations come from employee error than from outside attacks, according to an article written by Lucia Giles, Sr. Content Marketing Manager, Vanta. The article covers a recent survey conducted by Vanta regarding HIPAA risks at various healthcare organizations.
Key findings from the 600 survey participants:
60% reported HIPAA-related incidents or “near misses” have occurred at their workplaces.
49% of HIPAA-related incidents are due to internal employee errors, like misdirected emails, improper record disposal, or failure to follow standard procedures.
41% of respondents reported evolving regulations as the top barrier to remaining HIPAA compliant.
33% of healthcare organizations perform yearly vendor risk analyses. 83% of organizations provide HIPAA compliance training.
Source: https://www.vanta.com/resources/ hipaa-violation
Revised complaint procedures for labs
Chapter 5 of the State Operations Manual (SOM), Complaint Procedures, has been revised, according to The Centers for Medicare & Medicaid Services (CMS).
Key updates:
• Subsections are now included for “laboratories with Certificates of Compliance, Certificates of Registration, and temporary testing sites.”
• State Agencies and CMS now have 10 business days to send labs Form CMS-2567 and three business days to look into IJ complaints. Three business days are allowed for State Agencies and CMS to “send Form CMS-2567 to laboratories with immediate jeopardy findings” and perform “an on-site revisit survey before imposing principal sanctions.”
• Instructions for looking into transfusion-related fatalities (TRF) are now included.
Do you have a proficiency testing question?
MLO’s popular column, “Dear API Abby,” is back to answer proficiency testing questions.
No matter is too big or too small for the Dear API Abby experts! Feel free to share your most important proficiency testing conundrums at editor@mlo-online.com. Answers to your questions might appear in a future column (the next one will be in the November 2025 issue). Don’t worry, we won’t share your name or that of your laboratory in the article!
Order signed regarding tariffs
An Executive Order was signed by President Trump on July 7th regarding tariff rates. Additionally, the expiration date on certain tariffs was extended to August 1, 2025, according to a fact sheet.
Key points:
• Several countries will be “subject to new reciprocal tariff rates designed to make the terms of our bilateral trade relationships more reciprocal over time and to address the national emergency caused by the massive U.S. goods trade deficit.”
• The tariff rates for some countries will be higher or lower than the
amounts originally announced, in some cases.
• 14 countries were notified by letter of updated tariff rates.
Connection found between hormone therapy use and breast cancer
National Institutes of Health (NIH) researchers recently published results showing a connection between hormone therapy use and breast cancer risk in women under 55.
According to a release, the scientists “discovered that women treated with unopposed estrogen hormone therapy (E-HT) were less likely to develop the disease than those who did not use hormone therapy.” The opposite was found for women who used estrogen plus progestin hormone therapy (EP-HT). Their risk of breast cancer was higher than those who were not treated with hormone therapy. The longer women used EP-HT, the higher their risk was. Additionally,“the association between EP-HT and breast cancer was particularly elevated among women who had not undergone hysterectomy or oophorectomy.”
The scientists hope their findings will aid clinical decision making.
The U.S. Department of Health and Human Services (HHS) announced a step in the initiative to eliminate hepatitis C (HCV), $100M in pilot funding. The grant is for prevention methods, diagnoses, treatment, and a cure.
The Hepatitis C Elimination Initiative Pilot was launched by the Substance Abuse and Mental Health Services Administration (SAMHSA) to expand access to HCV care and eliminate health disparities, specifically in patients experiencing homelessness, mental illness, and addiction.
HHS expects to award between 13 and 40 grants of $2,500,000 - $7,500,000 each “for the first two years.”
Dana-Farber Cancer Institute published two literature reviews that highlight incidence trends of early-onset gastrointestinal (GI) cancers, according to a release.
Key findings:
• Incidence of early-onset GI cancers is jumping quicker than all other early-onset cancers.
• Colorectal cancer still has the highest incidence rate, but other GI cancers like gastric, esophageal, and pancreatic are becoming more common.
• Even though guidelines advise adults to start screening at 45, under 20% of U.S. adults aged 45 to 49 underwent a colorectal cancer screening in 2021.
• From 2010-2019, new diagnoses of early-onset GI cancers jumped nearly 15%.
• People who were born in the year 1990 “are twice as likely to develop colon cancer and four times as likely to develop rectal cancer compared to those born in 1950, according to the authors.”
• More adolescents and young adults are being diagnosed with colorectal cancer.
The authors also highlight risk factors connected to early-onset GI cancers and treatment options. They emphasize the need for more research pinpointing why diagnoses are rising in younger people.
You can read the literature reviews in the British Journal of Surgery and in JAMA.
Study finds association between COVID-19 hospitalization and vitamin D deficiency
A new study conducted by the University of South Australia, King’s College London, and Guy’s and St Thomas’ NHS Foundation suggests a connection between COVID-19 hospitalization and vitamin D deficiency.
According to a University of South Australia release, “no association was found between low vitamin D and the risk of catching COVID-19.” Though, disease risk was connected to vitamin D levels in patients of Asian or African/ Afro-Caribbean heritage.
The researchers discovered that those in the vitamin D deficiency and vitamin d insufficiency groups had a higher risk of being hospitalized from COVID-19 than those with standard levels of vitamin D. These findings were “only seen in people of Caucasian backgrounds.”
Recognizing long COVID in
Rutgers Health scientists confirmed in a study that young children can develop long COVID, but they experience different symptoms. Rutgers reported their findings in a release.
Over 1,000 children under the age of five were studied, and 677 of them had a positive COVID test in their lifetime.
Forty hospitals and health systems were recognized on Forbes’ list of America’s Best Employers for Women 2025.
Forbes partnered with market research firm Statista to survey more than 140,000 women working at companies with at least 1,000 employees in the United States. Survey respondents were asked to rate their current employers in areas such as pay equity, advancement opportunities, parental leave, work-life balance, benefits for childcare or eldercare, and the company’s handling of incidents related to sexual misconduct and discrimination. Statista analysts also researched the percentage of women in executive and board positions at each company.
700 companies made the list. Forty healthcare organizations with their rankings on the list are as follows:
4 Children’s Healthcare of Atlanta (Atlanta, GA)
6. Hoag (Newport Beach, CA)
8. Nationwide Children’s Hospital (Columbus, OH)
13. Cook Children’s Health Care System (Fort Worth, TX)
20. University of Tennessee Medical Center (Knoxville, TN)
21. New York-Presbyterian Hospital (New York, NY)
22. Sarasota Memorial Hospital (Sarasota, FL)
25. St. Jude Children’s Research Hospital (Memphis, TN)
29. Yale New Haven Health (New Haven, CT)
33. Houston Methodist (Houston, TX)
36. Arkansas Children’s Hospital (Little Rock, AR)
38. Boston Medical Center (Boston, MA)
44. Sutter Health (Sacramento, CA)
47. Mercy Medical Center (Baltimore, MD)
51. UC Davis Health (Sacramento, CA)
52. UMass Memorial Health (Worcester, MA)
81. North Kansas City Hospital (Kansas City, MO)
93. Fred Hutch Cancer Center (Seattle, WA)
94. Roswell Park Comprehensive Cancer Center (Buffalo, NY)
101 of them were classified as likely experiencing long COVID.
Reported symptoms differed with each age group. Participants two and under with long COVID experienced:
• Trouble going to sleep
• Fussiness
• Loss of appetite
• Stuffy nose
• Coughing
Participants aged 3-5 with long COVID experienced:
• Coughing
• Loss of energy
• Feeling sleepy during the day
105. Baptist Health System (San Antonio, TX)
109. Penn State Health (Hershey, PA)
128. University of Virginia Health System (Charlottesville, VA)
133. BayCare (Clearwater, FL)
141. University of Rochester Medical Center (Rochester, NY)
149. Denver Health (Denver, CO)
152. Guthrie (Sayre, PA)
167. OhioHealth (Columbus, OH)
168. Tucson Medical Center (Tucson, AZ)
170. Duke University Health System (Durham, NC)
177. MD Anderson Cancer Center (Houston, TX)
178. Cincinnati Children’s (Cincinnati, OH)
179. Cedars-Sinai Health System (Los Angeles, CA)
197. UW Medicine (Seattle, WA)
206. Lake Charles Memorial Health System (Lake Charles, LA)
220. Main Line Health (Radnor, PA)
221. Health First (Rockledge, FL)
222. Jupiter Medical Center (Jupiter, FL)
231. BJC Health System (St. Louis, MO)
250. WakeMed (Raleigh, NC)
251. ChristianaCare (Newark, DE)
The study is published in the Journal of the American Medical Association Pediatrics. The authors hope their findings help physicians diagnose long COVID in children.
Rutgers professor and lead investigator for the Collaborative Long-term study of Outcomes of COVID-19 in Kids (CLOCK), Lawrence Kleinman stated in a release: “The COVID pandemic began with a myth – that children are spared its ill effects. In contrast, many children were sick with COVID, and we now have a new chronic illness emerging.”

By Stephen Bishop, MBA, MS, CLS, MLS(ASCP)CM, CPHQ
Respiratory infections represent both a persistent and significant global health burden, necessitating accurate and timely diagnostic capabilities for effective patient management, public health interventions, and outbreak control.1 The historical trajectory of diagnostic methods for infectious diseases, particularly those affecting the respiratory system, has been a dynamic response to evolving clinical needs, consistently pushing for
See test online at https://ce.mlo-online.com/courses/Beyond-the-benchHow-artificial-intelligence-is-redefining-respiratorypathogen-diagnostics-in-the-clinical-laboratory Passing scores of 70 percent or higher are eligible for 1 contact hour of P.A.C.E. credit.
LEaRning oBJECtiVEs
Upon completion of this article, the reader will be able to:
1. Discuss the utility for the advancement of respiratory pathogen diagnosis.
2. Discuss timelines of respiratory illnesses and the development of laboratory testing with each.
3. Define the limitations of antigen testing in the identification of respiratory pathogens.
4. Describe the different subsets of AI and each of their purposes in the use of respiratory pathogens identification.
increased sensitivity, specificity, and speed in identifying causative agents. 2 This continuous evolution underscores the pivotal role of clinical diagnostics in mitigating the impact of respiratory illnesses.
Artificial intelligence (AI) now emerges as the next frontier in the evolution of respiratory pathogen testing. It offers groundbreaking computational abilities to enhance diagnostic speed, improved accuracy, and dramatically reduced turnaround times. This signifies that AI is not merely an incremental improvement but a foundational advancement capable of bridging critical diagnostic gaps, leading to more proactive, precise clinical decision-making, and ultimately, better patient outcomes and reduced healthcare burdens.
Initial methods for respiratory illness identification relied solely on physical findings and symptoms. The Greek physician Gelan, in the first century, described symptoms of TB (tuberculosis)

You can be the hero of your lab! SEKURE® sets the standard for accurate and timely Clinical Chemistry results which help drive better health outcomes.
At SEKISUI Diagnostics, we are committed to providing high quality SEKURE® Clinical Chemistry Reagents made in North America providing fast and easy access to the products you need to help your laboratory maximize productivity while minimizing costs.
To learn more about our clinical chemistry reagent products scan the QR code or go to sekisuidiagnostics.com/clinical-chemistry


1882 gram stain invented
Late 1800s - 1970s Culture and microscopy
allowed for rapid differentiation of bacteria (gram-positive/negative), guiding early empiric antibiotic selection.
Foundation of microbiology; isolation of infective pathogens, though slow (days to weeks for results).
1940s Viral cultures "gold standard" for viral infection diagnosis, but labor-intensive and slow.
1960s direct fluorescent antibody (dFa) tests Early antigen detection method for viral respiratory pathogens.
1980s Rapid antigen tests
First rapid bacterial antigen tests, setting a precedent for quick diagnostics.
1985 pCR invented Revolutionary molecular technique enabling rapid amplification of dna/Rna, leading to highly sensitive and specific detection.
1990s Ridts become commonplace popular due to testing speed and ease of use, but lower sensitivity.
1991 Rt-pCR for influenza detection single-target pCR used for a respiratory pathogen.
2009 H1n1 pandemic
2010s Rapid flu/RsV antigen tests
2020 CoVid-19 pandemic
Catalyst for pCR use in clinical labs to detect viral respiratory pathogens.
Routine use for flu/RsV detection. overall quality for antigen tests improved, still less sensitive than pCR.
unprecidented development of pCR and antigen-based tests; multiplex pCR becomes commonplace
present-Future ai-enhanced molecular assays ai integration into respiratory pathogen diagnostics for assay optimization and outbreak forecasting.
Table 1 general timeline of detecting respiratory pathogens in the clinical laboratory.
as night sweats, fever, and hemoptysis.3 From the mid-1800s, microbiology testing relied heavily on microscopy and cultures.4 Hans Christian Gram’s invention of the Gram stain led to significant breakthroughs in identification and classification of bacteria. 5 But even then, it was not until the 1940s that Influenza cultures, using mammalian cells and or embryonated eggs, became the “gold standard” for identifying the virus.
Nearly a half century later, in 1985, Kary Mullis invented the polymerase chain reaction (PCR), ultimately leading to significant strides in the ability to identify respiratory pathogens.6 For Influenza, specifically, the advent of reverse transcriptase (RT) PCR in 1991 facilitated the detection of the virus.7 Although RT-PCR was available and in use during the 1990s and 2000s, it was not routinely used to detect respiratory pathogens. Influenza and other respiratory pathogens were primarily identified using several methods, including enzyme-linked immunosorbent assay (ELISA), immunochromatographic tests (RIDT), direct fluorescent antibody tests (DFA), and various types of cultures.8 In 2009 during the Influenza A (H1N1) Pandemic, single target PCR became the principal method for identifying respiratory pathogens in clinical laboratories.8 The H1N1 pandemic shifted the paradigm for molecular diagnostics, acting as a catalyst for clinical laboratories to adopt new technologies to better respond to the needs of their communities.
A little more than a decade later, the COVID-19 pandemic further accelerated the adoption of PCR for respiratory pathogen detection. Several US manufacturers gained Emergency Use Authorization (EUA) from the Food and Drug Administration (FDA) in 2020 for multiplex PCR tests that could detect multiple targets in a single assay, including SARS-CoV-2. The COVID-19 pandemic demonstrated how rapidly new molecular tests, especially multiplex assays, could be developed and integrated into clinical practice and with a high demand, comprehensive molecular tests became routine. Furthermore, the COVID-19 pandemic solidified the use of multiplex PCR as a common diagnostic tool, as opposed to earlier PCR assays with single targets.
While PCR was established as the new “gold standard” for respiratory pathogen identification, antigen tests also rose to prominence due to their simplicity and speed. These tests allow for the rapid identification (10–15 minutes) of the target virus, leading to quick clinical decision making. They are especially valuable during the flu and RSV (Respiratory Syncytial Virus) seasons due to their prevalent availability and ease of use. Additionally, antigen tests are significantly less
Regardless of their limitations, antigen tests still have valuable clinical utility and should be complimentary to molecular methods.
expensive than their PCR counterparts and have less regulatory burden, since most tests are CLIA (Clinical Laboratory Improvement Amendments) waived.
However, antigen tests have natural limitations when compared to molecular diagnostic methods. Lower levels of sensitivity make these tests less useful when patients do not display symptoms or when the viral load is below detection. For example, during the COVID-19 pandemic, the Centers for Disease Control and Prevention (CDC) recommended that repeat testing of antigen tests for SARS-CoV-2 be performed to increase diagnostic confidence because a single test could not definitively rule out an infection. Additionally, antigen tests are affected by illness onset time (when viral loads are typically peaking), specimen quality, and the prevalence of the target pathogen in the population.9 Regardless of their limitations, antigen tests still have valuable clinical utility and should be complimentary to molecular methods. See Table 1 for a summary of the timeline.
The field of respiratory pathogen diagnostics continues to rapidly evolve. Current efforts focus on further decreasing
Cepheid delivers high-performing test results, with up to 99% PPA for Xpert® Xpress CoV-2 plus^ — eliminating the uncertainty.
your standard



Machine Learning identifies rules and patterns in data without explicit programming; algorithms autonomously discover governing principles.
deep Learning advanced ML using multi-layered ai architectures to interpret raw digital images; manages “big data.”
natural Language processing (nLp) analyzing unstructured textual data (e.g., clinical notes); transforming free text into structured information.
discerning complex patterns in data. • predicting pCR success/failure
• optimizing pCR reagents (primers, probes, etc.)
• predicting the impact of mismatches
• improving dna/Rna profiling quality
interpreting complex datasets (e.g., genomic sequencing, mass spectrometry); constructing predictive models.
Extracting crucial clinical features; disease classification; creating coherent patient histories from voice input; highlighting significant medical points.
turnaround times, expanding the use of less invasive sample types (self-collected nasal swabs), and improving diagnostic stewardship to ensure appropriate test utilization.10 Future developments are likely to include the emergence of new drugs effective against a broader range of respiratory viruses, which will further justify and necessitate the extensive use of highly sensitive and specific multiplex assays to guide targeted therapies.11
The new frontier
A future development that lies beyond the bench is the integration of artificial intelligence into major segments of respiratory pathogen detection. AI is an encompassing technology with powerful subsets that transform how data is analyzed to solve complex problems. Among these, machine learning (ML), deep learning (DL), and natural language processing (NLP) stand out for their distinct capabilities and extensive application in respiratory pathogen diagnostics. While ML forms the foundational subset of AI focused on learning from data, DL represents a more advanced form utilizing multilayered neural networks. NLP, on the other hand, empowers AI to understand and process human language.12 A summary of the subsets of AI is shown in Table 2. Machine learning is one of the foundational subsets in the AI diaspora. It involves the creation and design of algorithms that learn from the data it analyzes. Learning is then used to automatically identify patterns and forecast outcomes while removing (or minimizing) human manipulation. In terms of respiratory pathogen diagnostics, machine learning can be effectively leveraged to predict primer specificity and sensitivity, and to optimize primer design. For example, ML can study various factors known to influence primer performance, including primer sequence, length of the primers, melting temperatures (Tm), and concentrations. By learning from datasets of successful and unsuccessful PCR reactions, ML models can distinguish complex relationships between these parameters and the outcome of the assay.13
• accelerating Rt-pCR diagnosis
• Enhanced Multiplex pCR accuracy
• ”smart pCR” thermocyclers
• analyzing pCR requests, taking certain details into account
• automating result interpretation
Deep learning, a separate branch of AI that builds on ML, uses layers of neural network architecture to solve more complex and abstract problems. It does so by autonomously learning which combination of neural networks provide optimal solutions. DL offers a significant solution to accelerate RT-PCR diagnosis by applying neural networks that can predict results with a high degree of confidence. This capability is particularly useful for urgent diagnoses, where results are critical for efficient patient management and ideal allocation of hospital resources. The acceleration of RT-PCR diagnosis through deep learning has direct and significant clinical implications, especially during pandemics. By enabling an earlier prediction of results, it optimizes the utilization of critical healthcare resources (e.g., isolation rooms) and

facilitates faster public health responses, demonstrating AI’s capacity to enhance operational efficiency in high-pressure situations.14
A more specialized subset of AI that specializes in understanding human language is natural language processing. The major capability of NLP is taking unstructured data, such as text, notes, voice transcription, and other written forms of data, and converting it into structured data. NLP utilizes both ML and DL models to accomplish the transformation of unstructured data into structured data, which can be used to









Scan code to go directly to the CE test.
further enhance the ML and DL models it used (unsupervised, autonomous learning).15 An example of NLP advancing respiratory diagnostics would be the ability to link aspects of a patient’s electronic health record (EHR), such as history, physician notes, medical codes, and medications, into coherent and comprehensive summaries that can better inform a physician about which tests could be of value to the patient. NLP can reduce administrative cognition, allowing for more time to be spent on higher value tasks and reducing the time needed to make clinical decisions.16
Additionally, NLP can automate the interpretation of pathology and laboratory reports that are associated with PCR assays, including those used in respiratory pathogen detection. NLP models can easily analyze textual pathology reports that often accompany PCR (and other molecular methods), allowing for rapid identification of key findings, such as identified pathogens, mutations, insertions, deletions, etc.17 By automating these processes, manual review of the reports is minimized while essential information is communicated quickly.
Machine learning is one of the foundational subsets in the AI diaspora. It involves the creation and design of algorithms that learn from the data it analyzes
Due to its unmatched capabilities, AI is poised to be a pivotal advancement, bridging critical diagnostic gaps that currently contribute to inappropriate treatment, suboptimal patient outcomes, and increased healthcare costs. This development suggests a profound paradigm shift from reactive, and often delayed, diagnostic processes to more proactive, precise clinical decision-making. By delivering earlier and more accurate insights, clinical laboratories can leverage AI in respiratory pathogen detection for timely interventions, potentially preventing disease progression while alleviating administrative burdens on healthcare systems.12
Concluding
The trajectory of respiratory pathogen detection has significantly evolved from culture-based methods and stains to rapid antigen-based tests and progressively sophisticated molecular techniques. The advent of multiplex PCR further advanced respiratory pathogen detection by allowing for simultaneous identification of multiple pathogens from a single sample. This greatly improved efficiency and diagnostic utility. At the same time, antigen testing provides accessible, rapid, and often point-of-care solutions, crucial for quick screening and initial management, particularly during outbreaks. Looking forward, artificial intelligence is poised to further transform respiratory pathogen detection, with clinical laboratories playing a pivotal role in leveraging AI to enhance diagnostic accuracy, optimize assay development, improve
documentation, and facilitate early detection of emerging pathogens. Its successful integration will depend heavily on collaborative, interdisciplinary approaches that prioritize ethical considerations, robust validation, and continuous adaptation, ensuring that AI serves as a powerful ally in the ongoing fight against respiratory pathogens.
1. Esposito S, Mencacci A, Cenci E, et al. Multiplex platforms for the identification of respiratory pathogens: Are they useful in pediatric clinical practice? Front Cell Infect Microbiol. 2019;9:196. doi:10.3389/ fcimb.2019.00196.
2. Vemula SV, Zhao J, Liu J, et al. Current approaches for diagnosis of influenza virus infections in humans. Viruses. 2016;8(4):96. doi:10.3390/ v8040096.
3. Daniel TM. The history of tuberculosis. Respir Med 2006;100(11):1862-70. doi:10.1016/j.rmed.2006.08.006.
4. Smith, K. How TB diagnostics have evolved since the second century. ASM.org. March 22, 2021. Accessed July 28, 2025. https://asm.org/articles/2021/march/ how-tb-diagnostics-have-evolved-since-the-second-c.
5. Anekwe, L. Hans Christian Gram: The biologist who helped investigate bacteria. New Scientist. September 13, 2019. Accessed July 28, 2025. https://www.newscientist.com/ article/2216418-hans-christian-gram-the-biologist-who-helped-investig ate-bacteria/.
6. Khehra N, Padda IS, Swift CJ. Polymerase chain reaction (PCR). In: StatPearls. StatPearls Publishing; 2025.
7. Kumar S, Henrickson KJ. Update on influenza diagnostics: Lessons from the novel H1N1 influenza A pandemic. Clin Microbiol Rev 2012;25(2):344-61. doi:10.1128/CMR.05016-11.
8. Patel, SN., Gubbay, JB. Impact of pandemic influenza A (H1N1) on laboratory services. National Collaborating Centre for Infectious Diseases. Published 2012. Accessed July 28, 2025. https://nccid.ca/publications/ impact-of-pandemic-influenza-a-h1n1-on-laboratory-services/.
9. Testing for COVID-19. CDC. March 31, 2025. Accessed July 28, 2025. https://www.cdc.gov/covid/testing/index.html.
10. Allerton J, McKeown A. The Next Step for Respiratory Diagnostics. ID Transmission. other. February 11, 2025. Retrieved July 28, 2025, from https://www.idtransmission.com/testing/ the-next-step-for-respiratory-diagnostics.
11. Esposito S, Mencacci A, Cenci E, et al. Multiplex platforms for the identification of respiratory pathogens: Are they useful in pediatric clinical practice? Front Cell Infect Microbiol. 2019;9:196. doi:10.3389/ fcimb.2019.00196.
12. Dien Bard J, Prinzi AM, Larkin PMK, Peaper DR, Rhoads DD. Proceedings of the Clinical Microbiology Open 2024: Artificial intelligence applications in clinical microbiology. J Clin Microbiol 2025;63(4):e0180424. doi:10.1128/jcm.01804-24.
13. Lee, S. Optimizing PCR primers for microbiological analysis. Number Analytics // Super Easy Data analysis tool for Research. June 10, 2025. Accessed July 28, 2025. https://www.numberanalytics.com/blog/ optimizing-pcr-primers-microbiological-analysis.
14. Lee Y, Kim YS, Lee DI, et al. The application of a deep learning system developed to reduce the time for RT-PCR in COVID-19 detection. Sci Rep. 2022;12(1):1234. doi:10.1038/s41598-022-05069-2.
15. Natural language processing in healthcare medical records. ForeSee Medical. Accessed July 28, 2025. https://www.foreseemed.com/ natural-language-processing-in-healthcare.
16. Clinical NLP - how to apply NLP for EHR optimization. Maruti Techlabs. Accessed July 28, 2025. https://marutitech.com/ nlp-for-electronic-healthcare-record/.
17. Senders, J. T., Cote, D. J., Mehrtash, A., Wiemann, R., Gormley, W. B., Smith, T. R., Broekman, M. L., Senders JT, Cote DJ, Mehrtash A, et al. Deep learning for natural language processing of free-text pathology reports: a comparison of learning curves. BMJ Innov. 2020;6(4):192-198. doi:10.1136/bmjinnov-2019-000410.

Stephen Bishop, MBA, MS, CLS, MLS(ASCP)CM, CPHQ is currently the Market director of Laboratory services at CommonSpirit Health, Southern California s tephen is passionate about healthcare leadership, clinical laboratory education, and process improvement.




















By Lisa-Jean Clifford
As digital pathology and artificial intelligence (AI) continue to transform diagnostic medicine, laboratories find themselves at a timely and critical juncture. These technologies are not simply enhancements, they represent a fundamental shift in how clinical images and data are managed, routed, shared, viewed, interpreted and presented to pathologists. Laboratories that wish to remain at the forefront of innovation must evolve beyond traditional automation and digitally replicating their manual workflows.
Instead, the lab that successfully implements these solutions must carefully evaluate its technical infrastructure to accommodate complex, image-centric workflows, multi-source data integration, and AI-assisted analysis. This evolution requires careful analysis and review of platforms that not only handle high-resolution whole slide images (WSIs) but also enable interoperable communication across diverse systems—such as scanners, LISs, EMRs, EHRs, and archives—using both native file formats and standardized protocols like DICOM.
Successful implementation of digital pathology and AI depends upon a robust informatics ecosystem that supports interoperability and real-time data exchange between your applications. This includes information that will be displayed
in your viewer such as WSI’s, structured annotations, snapshots, AI overlays, and results outputs, but it also includes patient-specific case information you traditionally see in an LIS. These tools must be securely embedded within workflows, ensuring compliance with privacy regulations, while remaining scalable for multi-site deployments.
And this transformation is not solely technical. It requires training and cultivating a digitally fluent workforce, with training initiatives that enable pathologists, lab (and scanning) technicians to navigate the components of the process seamlessly and accurately.
Assess current infrastructure preparedness Before implementing new technologies, it is essential for laboratories to assess their existing systems and infrastructure. This includes evaluating scanner compatibility, data storage capabilities, and network bandwidth to ensure readiness for high-volume imaging, robust case routing and AI integration. Understanding what’s already compatible and supporting this initiative can help identify gaps, avoid redundant investments, and lay the foundation for seamless upgrades. A thoughtful audit sets the stage for informed decisions and smoother transitions into digital pathology and automation.

Key considerations include the following:
Scanner selection: Do you already have scanners in place? If so, are the digital solutions you are evaluating compatible with all of them? Do the scanners fit the needs of your organization in terms of volumes, speed, and quality of scanning? Are they dated or current in terms of the technology? If they aren’t, or you don’t have scanners, these are all items to consider in your evaluation and acquisition of scanners.
Keep in mind that the better digital platforms will support multiple scanner brands and models, enabling you to mix and match the scanners that best suit your organization’s needs.
Information management system(s): Is your LIS/EMR/EHR interoperable or compatible with other systems or applications? Is it an older, legacy system that will have limitations or challenges with being able to send and receive real-time data messages through standard methods of integration? Can your digital solution providers help bridge any of these gaps or do they have ways they can work around them in order to provide a seamless workflow for your pathologists and your technologists?
If your information system or “source of truth” for the patient is current and easy to integrate with other solutions, do you have one or multiple you are
looking to integrate with? Are you a multi-site entity or single location with one LIS or one version of that LIS?
All of these are points to consider when determining: 1) Which digital solution to select, and 2) If there are other infrastructure changes you need to make to ensure that your applications are able to speak to each other effectively.
Network bandwidth: Most robust digital solutions today are web-based, as is the storage for these large images. It is essential to understand what your current network supports and to plan to make modifications prior to implementing a digital platform. Speed and performance are a huge factor in the successful usage and adoption of your platform.
Most digital solutions are going to be optimized for performance, but internet and network bandwidth are two things that no vendor can account for. There are certainly things like load balancing and viewer performance that are important parts of the development and tuning process of vendors, however, providing the proper bandwidth and connectivity is something that the lab — or your IT department — will need to plan on.
Storage options: Preplanning is an important step here as well. Knowing whether you are going to archive all of your images or some of your images and for what amount of time is a key consideration.
Also understanding your options and selecting the one (or two) that are right for you is important. Are you planning to store locally/onsite? In the web? Does your digital solution provider offer both short- and long-term storage? Are you looking to use one of the large storage vendors (Google, AWS, Azure)? Understanding the price difference between these options, and if your digital solution provider can integrate bi-directionally with them is also a fundamental consideration.
On this note — any decision you make in this category can be easily changed.
A successful digital pathology deployment depends upon integration, real-time data exchange, and true interoperability.
Support for image formats: Enables streamlined viewing, image sharing, and best of breed selection for your organization across platforms. Are you looking to integrate your other ‘ologies’ and have a cross-patient perspective by
being able to collocate radiology and pathology images? If so, you also need to ensure that your systems support DICOM and integration with VNRs. Open APIs and HL7: Enable seamless connectivity with LIS, AI algorithms, other lab applications and modules, and advanced analytics platforms. Vendor-neutral solutions: Avoid vendor lock-in by selecting digital platforms that offer interoperable viewers, databases, workflows, and reporting.
Choose AI vendors and algorithms that align with your needs
AI algorithms should be carefully considered and evaluated to ensure that you address your specific clinical needs rather than adopt them as generic tools. Successful integration requires a thoughtful alignment by your digital pathology solution and the AI vendor. Those who have formed partnerships have put a great deal of thought and technical evaluation into the integration between the capabilities of their AI outputs and the digital workflow and visual representation to the pathologist. Whether it’s assisting with tumor detection, streamlining case triage, or supporting specific diagnosis and cancer grading, AI solutions should be targeted to enhance clinical workflows and improve decision-making. By integrating AI deployment directly within your digital platform’s viewer, you are enabling your workflow to be grounded in the realities of patient care and operational demands, ensuring that your laboratory can have meaningful impact, increased efficiency, and better outcomes.
Modernizing your lab’s infrastructure isn’t a single upgrade, it’s a strategic transformation. By focusing on compatibility, clinical utility, and scalable systems, labs can future-proof their operations and unlock the full potential of digital pathology and AI.

Lisa-Jean Clifford has been a noteworthy leader in the high-tech healthcare solutions space for more than two decades. l isa-Jean’s passion for making a positive impact on the lives of patients through technology can be traced back to her tenure at McKesson and iDX, now ge healthcare, where she served in vital business development and marketing roles, and to Psyche s ystems, an lis solution provider, where she was the C eo for eleven years. she is currently the President at Gestalt Diagnostics.

By Richa Bedi, PhD, MHA, MS, MLT(ASCP); Carrie V. Vause, MS; Jane M. Caldwell, PhD
Patients suspected of having an acute or chronic inflammatory condition are often tested for inflammatory markers.1 Erythrocyte sedimentation rate (ESR), frequently referred to as a “sickness indicator,” is an established, widely used test and can be used as a general marker of inflammation 2 both in acute diagnosis and monitoring of treatment and severity of chronic conditions. 3 Measurement of erythrocyte sedimentation provides clinically valuable information about a patient’s condition not provided by C-reactive protein (CRP) alone. CRP is typically associated more with acute inflammation and less with cancer and chronic or diffused inflammatory conditions. While ESR should not be used alone to diagnose a medical condition, it can help determine severity of an established condition or as a measure to lead to a diagnosis in combination with other tests or procedures. ESR is commonly performed when there is a
suspicion of any number of inflammatory conditions — including subclinical, acute, and chronic conditions — and can be elevated in systemic infections, orthopedic infections, bronchiolitis, giant cell arteritis, kidney, coronary, and autoimmune diseases, vasculitis, and certain cancers, among other conditions (see Table 1). 2-4
Erythrocyte sedimentation was originally observed by Polish physician Dr. Edmund Faustyn Biernacki in 1897 and further studied by Swedish hematologists and internists Dr. Robert Fahraeus and Dr. Alf Vilhelm Albertsson Westergren in the early 1900s.2,5 The presence of acute-phase plasma proteins causes an increase in RBC aggregation, and increased RBC aggregation is proportional to increased RBC sedimentation (see Figure 1). Historically, ESR has been measured with the standard Westergren
test developed by Dr. Westergren in 1921. This technique relies on placing diluted blood in a narrow, vertical tube and measuring the gravitational
anemia
coronary artery disease
Polymyalgia rheumatica
Pregnancy
Diabetes red blood cell abnormalities
infections (including bone and joint) rheumatoid arthritis
inflammation
Systemic vasculitis
Kidney disease thyroid disease
Low serum albumen tissue damage
Lupus Waldenstrom macroglobulinemia
Lymphoma, myeloma and other cancers
additional plasma protein factors
2024: Sysmex rated #1 in System Reliability & Service.
2023: Sysmex rated #1 in System Reliability & Service.
2022: Sysmex rated #1 in System Reliability & Service.
2021: Sysmex rated #1 in System Reliability & Service.
2020: Sysmex rated #1 in System Reliability & Service.
2019: Sysmex rated #1 in System Reliability & Service.
2018: Sysmex rated #1 in System Reliability & Service.
2017: Sysmex rated #1 in System Reliability & Service.
2016: Sysmex rated #1 in System Reliability & Service.
2015: Sysmex rated #1 in System Reliability & Service.
2014: Sysmex rated #1 in System Reliability & Service.
2013: Sysmex rated #1 in System Reliability & Service.
2012: Sysmex rated #1 in System Reliability & Service.
2011: Sysmex rated #1 in System Reliability & Service.
2010: Sysmex rated #1 in System Reliability & Service.
2009: Sysmex rated #1 in System Reliability & Service.
2008: Sysmex rated #1 in System Reliability & Service.
2007: Sysmex rated #1 in System Reliability & Service.
Awards are nice. Your lab running like a well-oiled machine is better.
This isn’t just an award. This is a service team that’s dedicated to keeping you and your laboratory running. At the heart of Sysmex’s service programs is a commitment that extends beyond instrument and laboratory operations. We strive to create a partnership that fosters trust, enhances peace of mind and allows you to focus on the things that truly matter. This represents a love of the laboratory and an appreciation for the laboratory scientists. Sysmex.com


For 18 consecutive years Sysmex has rated highest for System Reliability & Service.*
Hematology • Hemostasis • Urinalysis • Flow Cytometry • Informatics

sedimentation of RBCs over 60 minutes. Although the term sedimentation rate is used, RBCs do not fall at a constant rate; sedimentation occurs in three phases (Figure 1). The Westergren test has a 60-minute incubation to allow for full sample sedimentation and thus is subject to many environmental and operational variables, including ambient temperature fluctuations, tube angle (± 3°), operator technique, and interference from bench vibration, among others. The sample age and transport conditions prior to testing are important; CLSI and ICSH guidelines specify that Westergren ESR samples should be tested within 4 hours if stored at room temperature or 24 hours if refrigerated.6,7 A relatively short four-hour window of sample stability can be challenging for a routine lab test, especially when collection sites are widely dispersed. The Westergren method also requires significant handson time, exposes laboratory personnel to biohazards, and generates considerable disposable waste. Even modified Westergren methods that utilize automation to shorten testing time often retain these limitations.
As clinical laboratory staffing challenges persist, it can be difficult to devote hands-on time to manual Westergren tests. In response, photometric rheology has emerged as an alternative method of ESR to improve efficiency by minimizing operator intervention, reducing turnaround time, extending sample stability, and removing subjectivity associated with Westergren. It is faster because it does not measure the final amount of sedimented RBCs but measures rouleaux formation — which represents the preliminary aggregation of RBCs in the earliest stage of sedimentation. Photometric rheology offers a direct measurement of initial RBC aggregation in the lag phase of sedimentation thus is less affected by variables such as sample age, hematocrit, vibration, or room temperature. By utilizing micro-flow cell technology, modern photometric rheology analyzers maintain a highly controlled testing environment while maintaining temperature at 37°C, reducing variability from outside sources. The extended sample stability that is afforded by photometric rheology has a multitude of practical benefits — including greater flexibility in sample transport logistics and reduced redraws — and ultimately helps ensure result reliability.
A) Phases of red blood cell sedimentation B) ESR in Inflammatory Conditions
Lag phase: aggregation (rouleaux formation)
Sedimentation

Decantation: rbcs fall more rapidly and the rate is more constant
Packing: rbc aggregates pile up and sedimentation slows
Sedimentation
inflammation

Photometric rheology utilizes a measure of light transmission to directly detect rouleaux formation, which occurs during the earliest stage of the sedimentation process and ultimately determines the amount of RBC sedimentation. Within photometric rheology–based ESR analyzers, a whole blood sample is mixed, then 100 μl of sample is aspirated and pumped into a flow cell that disaggregates the RBCs. When the pump stops, light transmission through the sample is monitored as the RBCs begin to reaggregate (see Figure 2). Initially, light transmission through the disaggregated sample is low due to impact of the surface area of many individual RBCs blocking light. As RBCs begin to re-aggregate in the rouleaux formation (akin to a “stack of coins”), the overall surface area of the RBCs is reduced, and therefore more light is transmitted through the sample. Rouleaux formation begins within seconds of the pump stopping, and photometric rheology ESR analyzers can provide results in 15–20 seconds after sample mixing. In the context of inflammation, increased rouleaux formation due to plasma fibrinogen and globulins will cause increases in light transmission
that reflect changes in these acute-phase proteins associated with many inflammatory conditions. Photometric rheology ESR analyzers generate results in units of mm/hr and are correlated to the Westergren method.
Most clinical laboratories in the United States face critical staffing and funding shortages, particularly in the hematology department. Approximately 12,000 new graduates are needed yearly to meet demand, but only about 5,000 individuals complete their training programs.8 On top of this, only 12% of medical technologists plan on staying in laboratory medicine long term.9 There is 15% turnover of medical technologists, one of the highest turnover rates of all hospital employees.10 Within this group, there is already a vacancy rate for hematology laboratory staff of 16.6% with another 16.7% planning to retire in the next 5 years.11 Many labs are turning to relatively untrained new hires to fill staffing gaps. With staffing shortages at an all-time high, reduced hands-on times, quicker assay turnaround times, and shorter training requirements are paramount to laboratory efficiencies. By





















2017, 72% of labs had adopted modified or alternative ESR methods.7 Modified ESR, while having a shorter turn-aroundtime, still has many of the same environmental limitations as the Westergren method. Almost 1 in 3 testing facilities still rely on traditional techniques prone to environmental variability and limited sample stability. In 2025, there are a variety of automated ESR analyzers on the market that utilize photometric rheology, modified Westergren, and other alternate ESR methods (see Table 2).
The use of photometric rheology offers a compelling and easily adoptable solution to the required hands-on time and limited stability of Westergren and modified Westergren assays. These assays are correlated to the standard Westergren reference method but are engineered to improve laboratory efficiency by reducing hands-on time to seconds and turnaround time to minutes. Photometric rheology ESR analyzers are fully automated and less reliant on a technician’s skill and experience in performing the test. Therefore, there is less variability between users and shorter training times needed to successfully run the assay. The user-friendly automated workflow results in best-in-class precision and reproducibility between different operators and different labs. Longer sample stability — up to 28 hours at room
temperature and 48 hours refrigerated — exceeds traditional recommendations for Westergren and modified Westergren assays. As lab testing becomes more consolidated and vacancy rates increase, greater flexibility in transport logistics and testing start times help maintain result quality. Additionally, photometric rheology ESR analyzers help reduce waste and lower risk of biohazard exposure. They utilize easily available capped EDTA tubes and not per-test disposables specific to older ESR test methods. Photometric rheology analyzers do not require any special sample preparation or uncapping of sample tubes; in addition, the no hands-on transfers of biological fluids help users avoid unnecessary biohazard exposure. These features of photometric rheology ESR analyzers can reduce manual workload and accelerate result delivery thereby addressing key pain points in today’s strained laboratory environments.
ESR tests are one of the most common routine lab tests, yet they still face considerable limitations. Photometric rheology represents a significant advancement in ESR testing. By minimizing environmental interference, reducing hands-on time and turnaround time, reducing user exposure to biological
samples, and extending sample stability, it enhances laboratory efficiency and safety. As labs continue to face staffing shortages and increased testing demand, adopting such technologies may offer a practical path forward for ESR tests.
1. Watson J, Round A, Hamilton W. Raised inflammatory markers. BMJ. 2012;344(feb03 1):e454. doi:10.1136/bmj.e454.
2. Tishkowski K, Gupta V. Erythrocyte Sedimentation Rate. StatPearls Treasure Island (FL).
3. Reed L. Value of automated ESR. Medical Lab Management. Published online 2013:12.
4. Assasi N, Blackhouse G, Campbell K, et al. Comparative value of erythrocyte sedimentation rate (ESR) and C-reactive protein (CRP) testing in combination versus individually for the diagnosis of undifferentiated patients with suspected inflammatory disease or serious infection: A systematic review and economic analysis [Internet]. Ottawa (ON): Canadian Agency for Drugs and Technologies in Health; 2015 Nov.
5. Grzybowski A, Sak J. A short history of the discovery of the erythrocyte sedimentation rate: LETTER TO THE EDITOR. Int J Lab Hematol 2012;34(4):442-444. doi:10.1111/j.1751-553X.2012.01430.x
6. CLSI Document H02-A5. Clinical and Laboratory Standards Institute WVR, Suite 2500.; 2011.
7. Bull BS, Caswell M, Ernst E, et al. ICSH recommendations for modified and alternate methods measuring the erythrocyte sedimentation rate. J Clin Pathol. 1993;46(3):198-203. doi:10.1136/jcp.46.3.198.
8. Clinical laboratory personnel shortage. ASCLS. Accessed August 1, 2025. https://ascls.org/workforce/.
9. Forging a Path to Workplace Wellness: Insights From the Diagnostic Lab. QuidelOrtho. 2024.

11. Garcia E, Kundu I, Kelly M, Soles R. The American Society for Clinical Pathology 2022 Vacancy Survey of medical laboratories in the United States. Am J Clin Pathol. 2024;161(3):289-304. doi:10.1093/ajcp/aqad149.

Richa Bedi, PhD, MHA, MS, MLT(ASCP) is the Director of Laboratory operations at Advocate Aurora Health in chicago, illinois. She e Sris responsible for laboratory leadership and spearheads initiatives to maintain compliance with accrediting bodies and quality improvement. her role encompasses strategic planning, quality assurance, and managing laboratory operations to ensure the highest standards of patient care.

Carrie V. Vause, MS is the Director of c ontent Development at the medical education company Medavera, Inc. She has over 17 years of experience in molecular research, education, and medical content development. Ms. Vause is published in peer-reviewed journals in cell and molecular biology and develops continuing education programs for healthcare professionals. her focus is the creation of medical content that educates providers and impacts patient care.






10. 2025 NSI National Health Care Retention & RN Staffing Report. NSI Nursing Solutions, Inc. Accessed August 1, 2025. https://www. nsinursingsolutions.com/Documents/Library/NSI_National_Health_ Care_Retention_Report.pdf.









Jane M. Caldwell, PhD is the executive director of the medical education company Medavera, Inc. and has over 25 years of diverse experience with research and development in multiple areas of epidemiology and molecular biology. She has published extensively in peer-reviewed journals, book chapters, and the popular press. Dr. caldwell recently worked as a consultant to troubleshoot algorithms for qP cr detection of co V iD-19 infections which improved the accuracy of the kits filed under the e mergency Use authorization.






































































































By Steve Dimmer

Within the steady rhythm of today’s laboratory, microbiology stands at a pivotal moment. Once quietly supporting infection control, these labs now drive the global response to pathogens that adapt faster than traditional methods can keep pace. New threats like Candidozyma (formerly Candida) auris, a deadly drug-resistant yeast, and persistent pathogens like Clostridioides (formerly Clostridium) difficile demand faster, more accurate testing methods.
Accurate pathogen identification and susceptibility testing are essential for guiding patient treatment and preventing outbreaks. However, laboratories now face a critical paradox: as the range of pathogens grows, efficiency must increase despite shortages in staff and resources.
Emerging microbiology challenges
Candidozyma auris
First reported in 2009, Candida auris — now Candidozyma auris — quickly became a global health concern due to its resistance to multiple antifungal drug classes, environmental persistence, and association with high mortality in healthcare settings.1 Detected on all inhabited continents by 2018, the CDC and WHO now classify the infection as an urgent threat and critical priority for the protection of global health.2
The laboratory identification of C. auris can be challenging, but recently, scientists have developed a chromogenic medium to identify the yeast.3 This is a prime example of where traditional microbiology approaches can assist in the detection and guided intervention of infections in healthcare settings. By producing distinct colors for C. auris, the chromogenic medium has been shown to correctly identify the majority of
C. auris isolates in early studies, with minimal false positives.4
Clostridioides difficile
Clostridioides difficile (C. difficile) continues to evolve as well, with hypervirulent strains causing severe, recurring infections that challenge even the most robust infection control efforts. Its capacity to form resilient spores and persist on surfaces complicates eradication — particularly in healthcare systems full of immunocompromised or susceptible patient populations.
Technological innovations in microbiology solutions
When it comes to these emerging threats, the field of microbiology has been quick to innovate, providing new solutions that empower clinical labs to better identify and take appropriate action in the face of growing infection risk. This innovation has been guided by two key themes: the need to reduce human error and improve consistency, and the ability to combine varied diagnostic platforms for a more holistic and accurate picture of infection.
Reducing human error and increasing consistency
Chromogenic culture media enable visual differentiation of pathogens like MRSA, VRE, CRE, and C. auris, reducing interpretation errors and streamlining workflows.4 In a more democratized approach that is helping advance microbiology performance, multiplex molecular panels can also integrate pathogen detection and resistance gene identification, shortening time-to-results and enabling targeted treatment.
The introduction and advancement of artificial intelligence–enabled data interpretation tools is also helping increase consistency in culture media analysis. 5 AI has the potential to help fill the knowledge gaps in skilled labor that are increasing in the lab by helping interpret test results and helping lab technicians feel confident in their results. Unfortunately, these tools are still in early stages, so while there’s vast potential, most systems are currently used in larger, more well-resourced microbiology labs and haven’t yet advanced to more widespread availability.
Combining advanced diagnostic platforms
The integration of molecular platforms, such as multiplex PCR, loop-mediated isothermal amplification (LAMP), and even CRISPR-based assays, has also further advanced detection, enabling labs to identify multiple pathogens and
resistance genes in a single run. Further, technological enhancements have helped reduce turnaround times from days to hours. PCR-based rapid detection, such as TaqMan assays for C. difficile ST1, provide accuracy, support infection control and enhance antimicrobial stewardship by reducing overtreatment. Each of these new tests has helped revolutionize microbiology—allowing us to improve efficiency and access to diagnostics to help treat and manage illnesses more effectively.

Candidozyma auris on chromogenic media.
However, adopting new technologies requires careful planning. Amid the challenges posed by the infections themselves, microbiology and clinical labs must also navigate industrywide logistical challenges such as a need for vendor consolidation and shortages in staff and resources.
According to a recent survey by the American Society for Clinical Pathology, “Staff layoffs, reduced hours, or hiring freezes can strain the workforce, leading to increased workloads and potential burnout.”6 While these operational changes may initially pose hurdles, they also offer an opportunity to rethink how these labs work and integrate across the industry. How can labs advance without compromising efficiency or quality?
Training lab staff and partnering with reliable vendors are essential to ensure these systems are used effectively. By balancing innovation with efficiency, microbiology labs can better detect and respond to the growing threat of new infections, protecting patients and public health alike.
For example, the notion of vendor consolidation can be ominous as lab leaders consider the internal resistance to change. However, consolidating around uniform platforms also offers immense benefits, such as reducing supply chain complexity, simplifying validation, and lowering training
requirements. A detailed cost–benefits analysis can help assess when it is the right time for each lab to consider this type of move, evaluating initial platform cost and change management against the longer-term benefits.
And while grappling with staffing shortages can also be daunting, rethinking who does what in a lab setting — and where automation or technology could lend a helping hand — may in fact identify new efficiencies moving forward. To take advantage of these emerging technologies, staff training is paramount. Introducing complex molecular or analytical methods requires sustained competency development and relationships with vendors who provide effective support.
Progress in microbiology demands both curiosity and clarity. In confronting emerging pathogens like C. auris and C. difficile, as well as their evolution with antimicrobial resistance, clinical microbiology laboratories must evolve by integrating technological innovation with efficient operations. Tools like chromogenic media, AI-enabled interpretation platforms, molecular assays, and emerging diagnostics offer comprehensive insight without compromising throughput. Strategic planning, including vendor standardization and staff training, ensures these technologies enhance rather than burden clinical workflows. With this balanced approach, microbiology labs can strengthen both diagnostics and public health preparedness.
1. Nutt K. Deadly climate change fungus targeted in drug project. The Times. Published July 6, 2024. Accessed July 25, 2025. https://www.thetimes.com/uk/scotland/article/ deadly-climate-change-fungus-targeted-in-drug-project-l0kbnmmwp.
2. Lyman M, Fox A, Zhu Y, et al. Epidemiology and clinical outcomes of Candida auris infections in the United States, 2017–2022. Open Forum Infect Dis. 2024;11(6):ofad681. doi:10.1093/ofid/ofad681.
3. Morales-López S, Parra-Giraldo CM, Ceballos-Garzón A, Rodríguez GJ, Álvarez-Moreno C, Rodríguez JY. Utility of CHROMagar Candida Plus for presumptive identification of Candida auris from surveillance samples. Published online November 2022. Accessed July 25, 2025. https://www.researchgate.net/publication/365291857.
4. Kordalewska M, Pasko MT, Kwon DH, et al. Retrospective whole-genome sequencing analysis distinguishes independent outbreaks of Candida auris in New York. Microbiol Spectr. 2024;12(3):e03564-23. doi:10.1128/spectrum.03564-23.
5. Reese H, Wallace M, Vugia DJ, et al. Multistate outbreak of echinocandin-resistant Candida auris infections linked to a skilled nursing facility — California, 2021–2022. MMWR Morb Mortal Wkly Rep. 2024;73(13):273-279. doi:10.15585/mmwr.mm7313a2.
6. Kelly SL, Rautemaa-Richardson R, Richardson MD. Molecular mechanisms of antifungal resistance. Manchester Fungal Infection Group. Published 2022. Accessed July 25, 2025. https://static1.squarespace. com/static/603ab50ab81d5532a0a4a42b/t/62e7f142e363ce5e988573fc/1 659367747105/1+Kelly+et+al.pdf.

Steve Dimmer is a s taff scientist and biological safety o fficer at Thermo Fisher Scientific. With over 30 years of experience in clinical microbiology and research, he combines scientific rigor with leadership to drive innovative product development and design excellence across the organization.
By Kara Nadeau
This year’s Medical Laboratory Observer (MLO) annual survey of laboratory professionals offers the most comprehensive snapshot yet, with a record-breaking 662 respondents—triple the number from last year—sharing their perspectives on job satisfaction, compensation, workforce dynamics, and professional development.
Survey findings reveal that while most medical laboratory professionals enjoy their work, taking pride in the vital role they play in patient care, it can come at the cost of mounting pressures and limited opportunities for advancement: Staff shortages, high turnover, burnout, dissatisfaction with salaries, undefined career ladders, and lack of support for continuing education.
The survey data underscores the urgency of investing in robust training and education, retention strategies, and long-term workforce development to safeguard the future of the profession.
For this article, MLO also reached out directly to members of the medical laboratory community to gather commentary on the state of the profession, which we present alongside the quantitative survey results data.
Additionally, we gathered qualitative insights by allowing survey respondents to provide comments to select questions within the online survey tool. These insights have been analyzed for key themes, which are included in this article, along with select comments from laboratory professionals presented anonymously.
Among the 662 medical laboratory professionals participating in this year’s survey (up from 220 in 2024), the majority were female (81%) and work in hospital laboratories (70%). There was representation from across a broad range of ages.
Looking at job titles, medical laboratory technicians (MLT) made up over one-third of survey respondents (33%), the highest representation of this role in the past three years (5% in 2024, 0.7% in 2023).
There were fewer respondents in laboratory director, manager, administrator and supervisor positions compared with previous years (28% in 2025, 41% in 2024, 73% in 2023). The next most represented title was medical laboratory scientist (MLS/MS) at 12% (14% in 2024, 3% in 2023).
Regarding experience, nearly half of those surveyed (48%) reported having 20+ years in the lab industry, and one-third (30%) 30+ years. Additionally, about one-third (32%) reported less than 10 years of experience, while the remaining 22% fell in the middle range (10-19 years of experience).
There was wide-ranging representation both in the size of labs and volume of testing among medical laboratory professionals who took part in the 2025 survey. While most respondents work in labs with 1-20 employees (40%), an additional 26% work in labs with 21-50 employees, and 34% in labs with 51-100+ employees.
Turning to annual test volumes performed by their labs, 32% were on the high end of between 1,000,001- 2M+, 13% between 500,001-1M, 22% between 100,001-500k, 10% between 50,001-100k, 7% between 25,001-50,000, and another 7% at less than 25,000. The remaining 8% responded “N/A.”
Nearly half of laboratory professionals surveyed (45%) have been with their current employer for five years or fewer, 25% between 6-14 years, 19% between 15-30 years, and 10% 30+ years.
When asked how many hours they work in a normal shift, more than half of respondents (52%) said they work 8 hours, which changed little since 2024 (56% of respondents). More respondents this year report working 12-hour shifts (11% up from 6% in 2024), 10-hour shifts (20% up from 16% in 2024), and 9-hour shifts (12% up from 9% in 2024).
Fewer of those surveyed report having fluctuating hours compared with last year (4% in 2025, down from 11% in 2024). As with last year, only 1% report working 6- or 7-hour shifts.
Looking at level of education, nearly half of those surveyed (46%) reported holding bachelor’s degrees, 33% associate’s degrees, 22% post-graduate degrees, and less than 1% said high school was their highest level of education.
When asked which certifications they held, nearly three-quarters of laboratory professionals (73%) cited they were certified by the American Society for Clinical Pathology, up from 63% in 2024. Those having earned Medical Laboratory Technician (MLT) certification rose as well, at 35%, up from 11% last year.
There was a decrease in survey respondents holding certification as Medical Laboratory Scientists (MLS/ MS) and Clinical Laboratory Scientists, the percentage of the former being 17% (down from 30% in 2024) and the latter 11% (down from 14% in 2024).

Mlt(aScP)
As for the organizations from which they received professional certifications, the majority (78%) reported the American Society for Clinical Pathology (ASCP). The next highest-ranking response was state certification at 10%, followed by American Medical Technologists (AMT) at 7%, and the National Credentialing Agency for Laboratory Personnel (NCA) at 6%.
A significant portion of those who selected “other” certification entities were international professionals commenting on their country’s official certification or licensure authority (e.g., Health and Care Professional Council United Kingdom, Medical Sciences Council of New Zealand, Philippine Regulations Commissione, Portuguese Ministry of Health).
The comments also uncovered a trend in specialty credentials in areas such as quality and safety (American Society for Quality), histocompatibility and immunogenetics (American College of Histocompatibility and Immunogenetics), and point-of-care testing (Association for Diagnostics & Laboratory Medicine).
There were fewer salaried medical laboratory professionals who took part in this year’s survey compared with last year (36% in 2025, down from 54% in 2024 and 72% in 2023) and more paid hourly (64% in 2025, up from 46% in 2024 and 28% in 2023).
Most survey respondents (68%) reported their salaries increased in 2024 (down from 73% last year), 29% stayed the




same (up from 23% last year) and 3% reported a decrease (down from 4% last year). Only 32% received a bonus as part of their 2024 compensation (68% reported no 2024 bonus).
When asked about their expected 2025 annual base salary, over half of respondents (58%) reported salaries between $45,000 and $95,000. On the high end of the compensation curve, 26% reported earning more than $100,000/year, including 6% earning over $151,000 annually. In the lower income bracket, 7% reported earning less than $40,000/year. Most (44%) expect a 2-4% pay increase this year.
Kristina Good, a Medical Laboratory Technician (ASCP) in Wisconsin, shared her thoughts on compensation, stating: “Like most lab professionals, I did not decide to work in lab for the pay. That being said, the rate of pay for lab professionals is often not proportional to the work that we do. It can be frustrating that lab professional pay is not high enough, as I feel this can discourage people from entering the lab profession.”

Amanda J. Lewis, MLS(ASCP), a Clinical Laboratory Quality Assurance Supervisor based in Texas, commented: “Too often, organizations fail to factor in the growth of demands and job complexity, particularly in rural regions that pay sub-market wages, as struggling systems attempt to adapt to reduced budgets.”
Employer benefit offerings remained robust, with most laboratory professionals surveyed receiving health insurance (94%), dental insurance (90%), a 401k or pension plan (90%), vision insurance (88%), PTO (89%), and life insurance (82%).
The quantitative survey results showed somewhat lower job satisfaction compared with last year. Those who reported being “very satisfied” dropped to 38% in 2025 from 44% in 2024, and those “somewhat satisfied” dropped to 41% from 44%. There was an associated increase in medical laboratory professionals who reported being “somewhat dissatisfied” at 17%, up from 9% last year. Those who are “very dissatisfied” changed little at 4% in 2025, up slightly from 3% in 2024.
“I love what I do,” said Good, who currently holds an associate of applied science degree as an MLT and is continuing her education through the University of Arkansas for Medical
Science (UAMS) with hopes to attain a bachelor’s of science degree in MLS in December 2025.
“My salary is not where I would like it to be, and this is a demanding field to be in, but it is also extremely fulfilling,” Good added. “I am proud to be a lab professional!”
Looking at the qualitative comments by survey respondents, most laboratory professionals report feeling satisfied with their jobs, often due to a passion for the work, supportive teams, and a sense of purpose. Examples of positive comments:
• “I work in a cancer clinic. I am very satisfied with the work I do. I see the difference we as a clinic make for our patients.”
• “I am valued and appreciated. I am also asked to help with lab projects, and I help train new techs and students.”
• “My organization and immediate reports are highly vested in improvement and advancement of myself and others. I feel valued.”
However, many still express frustration over issues like pay, leadership, and workload. Examples of neutral comments:
• “I enjoy my job, but if management was better, it would be 10x better.”
• “I love my job; I do not like how things are run at my job.”
• “Mostly satisfied. Could have opportunities for advancement.”
A smaller but vocal group feel deeply dissatisfied, citing burnout, toxic environments, and lack of growth opportunities. Examples of negative comments:
• “This is a very toxic environment… very horrible things said to me.”
• “No more growth potential. Same pay offered today as 35 years ago.”
• “I am very burnt out and desperate for a break.” When asked for the primary reasons they stay in their current positions, location/commute and work/life balance topped the list, at 52% and 47% respectively. Benefits (39%), salary (38%), team/culture (38%) and job security (32%) also ranked well, while 16% of those surveyed cited lack of other opportunities as their reason for staying.
Regarding job security, over half of medical laboratory professionals (56%) feel “very secure,” 31% “somewhat secure,” 9% “somewhat insecure,” and 3% “very insecure.” An analysis of the quantitative comments found the top three drivers of job security are:
• Staff shortages and hard-to-fill shifts
• Specialized expertise or leadership roles
• Personal performance and tenure
Specific comments provided:
• “My job can’t keep employees. So, I’m confident I can stay as long as I choose to stay.”
• “I am a very valuable team member as I am only one of two people who are trained as a generalist in my lab.”
• “The CEO knows my name and there’s talk of my future after I earn my bachelor’s degree.”
The top three drivers of job insecurity based on the comments are:
• Hospital or organizational financial instability
• Management and leadership issues
• Broader economic or political uncertainty
Specific comments provided:
• “Secure in my role, but unsure about the hospital’s budget.”
• “Always feeling judged, like others are looking for your mistakes.”
• “With federal funding changes, it’s not looking good.”
MLO asked medical laboratory professionals if they feel they have adequate opportunities for career advancement at their current jobs. The responses were nearly split between those who answered “yes” at 41% and “no” at 43%. An additional 17% report they were unsure about career advancement opportunities with their employers.
Commenting on career ladders and the need for them to match the pace of medical lab advancement, Lewis stated:
“Tomorrow’s med-techs will be held responsible for activities far from the bench, such as quality assurance review, basic IT interfacing, participation with departmental improvement initiatives on a multidisciplinary scale and data analytics, just as a starting point. Most labs though have yet to establish
Do you feel you have adequate opportunities for career advancement at your current job?
formal career progression ladders following the basic bachelor’s degree and ASCP credentialing.”
“While tuition reimbursement toward eligibility in ASCP is standard, few formalized developmental tracks exist for leadership, compliance, information technology or project management positions,” she added. “Micro-credentials, well-structured mentorship, and multi-step promotion would grant recognition and retention.”
Looking at the qualitative comments provided, the most common themes among those who feel they have adequate opportunities for career advancement in their current jobs included internal promotion practices, structured advancement ladders, and educational support.
Specific comments provided:
• “There are higher level positions available, and they prefer to hire from within...”
• “There are programs for advancement.”
• “They provide tuition assistance for MLS...”
The most common themes among laboratory professionals who feel their current employers don’t offer adequate opportunities included small organizations with few lab positions, limited advancement opportunities, lack of a career ladder, and education barriers.
Specific comments provided:
• “There are really only two positions at my job; lab manager and general lab technician.”
• “Short of taking over as a director or leaving entirely, I am as high as I can climb.”
• “No opportunities for tuition reimbursement if I wish to advance.”
When asked how satisfied they were with their lab’s education and training programs, 41% of survey respondents reported being “somewhat satisfied” (down from 48% in 2024), 30% “very satisfied” (up from 25% in 2024), 20% “somewhat dissatisfied” (up from 17% in 2024), and 9% “very dissatisfied” (down slightly from 10% in 2024).
Are you looking for hands-on materials to support your Medical Laboratory Science curriculum?
As a leader in clinical proficiency testing, API is developing new ways to provide colleges and universities with educational resources to enhance student learning.
Let us know what proficiency testing samples and curriculum support would be most useful for your classroom:












<$20,000$20,000-$24,999$25,000-$29,999$30,000-$34,999$35,000-$39,999$40,000-$44,999$45,000-$49,999$50,000-$54,999$55,000-$59,999$60,000-$64,999$65,000-$69,999$70,000-$74,999$75,000-$79,999$80,000-$84,999$85,000-$89,999$90,000-$94,999$95,000-$99,999$100,000-$110,999$111,000-$120,999$121,000-$130,99$131,000-$140,999$141,000-$150,999>$151,000
Those who contributed positive comments on their satisfaction levels cited benefits including tuition assistance, CEU platforms, clinical internship programs, and structured onboarding. Those who posted negative comments cited factors such as lack of formal structure, rushed training, financial burden on employees, lack of leadership support, lack of CE funding, and burnout due to having to “train while working.”
status, challenges, and opportunities
Nearly half of laboratory professionals surveyed (45%) reported it being “somewhat difficult” to hire qualified staff in the past 12 months, while 30% reported it being “very difficult.” Additionally, 13% indicated no difficulty, while 12% selected “N/A” as their response.
Over half (57%) reported their labs have experienced “moderate” staff turnover in the past year, 16% “high” turnover, and 22% “no turnover.” An additional 5% were unsure.
those reporting any impact (low, moderate, high), at 91%.
Nathan H. Johnson, PhD, MASCP, MLS(ASCP)DLM, SC, SLS, chair, Department of Laboratory Sciences, University of Arkansas for Medical Sciences, College of Health Professions in Little Rock, Ark., offered his thoughts on staffing shortages and their impacts, stating:
“There has not been an accepted laboratory manning standard in about 30 years. This makes the job of the laboratory director or manager difficult when documenting and communicating the need for new employees. The variation in automation also makes comparisons between labs difficult, but at the present time, that is probably the best option.”

“Younger Gen Y and Gen Z professionals are especially transient,” Lewis noted. “They quickly switch jobs if competing labs offer compensation increases, flexible scheduling or ‘non-toxic’ environments. Time-tested recruiting tactics such as job board ads and hiring incentives are becoming increasingly costly as turnover rates each year approach 20% in regions.”
When asked what impact the current shortage of medical personnel has on their lab’s operational efficiency, 41% reported a “moderate impact,” 34% “low impact,” 16% “large impact, and 9% “no impact.” Compared with last year’s survey results, there was no change in
“Staffing has consistently been a variable since I started working in lab in 2017,” said Good. “I cannot think of a single time in those eight years that our lab was fully staffed. It is a constant revolving door of working short, training traveling/temp staff, and training new staff. Just as we get close to full staffing, someone leaves or retires, and the cycle continues.”
Over three-quarters of laboratory professionals (77%) reported the current shortage of medical personnel did not cause their labs to outsource more tests during 2024, while 15% did engage in more outsourcing last year. An additional 8% of survey responded selected “other” with several providing comments on this selection.
Some laboratory professionals reported how they had experienced limited outsourcing due to staffing or sent tests to sister/reference facilities. Specific comments provided:
• “Occasionally need to refer tests due to staffing shortage”
• “Micro testing sent out to reference lab temporarily…”
• “Tests are consolidated or referred out as needed”
Others noted that outsourcing didn’t increase or that the lab took alternative steps, like hiring temps or foreign workers. Specific comments provided:
• “No outsource. They did bring in techs from the Philippines”
• “Not testing, but we are recruiting internationally for staff.”
• “Answer is NO… we are the reference lab.”
While automation to replace manual processes can help ease workforce burden, fewer reported their labs automating or further automating new procedures in 2024 compared with 2023 (39% down from 48%).
“Some burdens have been alleviated with automation, especially at high-turnaround pre-analytical zones of a lab,” Lewis commented. “Successful implementation, however, depends on the upskilling of staff so they can effectively employ and troubleshoot these systems.”
“The staff’s education on how to use and troubleshoot these technologies will be crucial in the years ahead,” she continued. “Adopting these technologies will unlock a sustainable future for clinical laboratories and enable them to overcome existing obstacles.”

Kara nadeau has 20+ years of experience as a healthcare/ medical/technology writer, having served medical device and pharmaceutical manufacturers, healthcare facilities, software and service providers, non-profit organizations and industry associations.



The New ACL TOP Family 70 Series systems with HemoHub Intelligent Data Manager provides an end-to-end frictionless workflow. Powerful automation and centralized data management deliver streamlined performance verification and preanalytical sample integrity checks for consistent, quality results to help reduce manual steps and optimize workflow. With trusted accuracy and smarter data at your fingertips, your lab can stay focused on higher-value activities.
See the efficiency. Trust the results. Werfen.com/70Series











powered by






The Werfen logo is a trademark of Werfen. HemosIL, ACL, ACL TOP, ACL Elite, ACL AcuStar, ReadiPlasTin, RecombiPlasTin, SynthASil, SynthAFax are trademarks of Instrumentation Laboratory Company, d.b.a Werfen, and/or one of its subsidiaries or parent companies and may be registered in the United States Patent and Trademark Office and in other jurisdictions. All other product names, company names, marks, logos, and symbols are trademarks of their respective owners. ©2025 Instrumentation Laboratory. All rights reserved.



Now that CLIA has approved the Doctor of Clinical Laboratory Science (DCLS), what can the industry do to raise awareness of the importance of our profession at this level? The history of laboratory medicine shows the tremendous contribution of our field, as well as the severe shortage of professionals at all levels. Will there be infighting between the various laboratory organizations or will there finally be a united position that will develop, recognize, and promote the high quality of care a DCLS can provide?
DEAR DCLS:
I too share your opinion that the DCLS has a valuable part to play in laboratory medicine and will be significant in helping healthcare settings and ordering providers with the level of expertise needed to champion appropriate test utilization which will drive down healthcare costs and improve patient care. Just as Pharm-Ds contribute to patient rounds by improving treatment plans, DCLS professionals will play a key role in advancing laboratory medicine. It has been a long time coming as those of us in the trenches have observed. It is simply impossible for clinicians to know the details and value of every laboratory test. As MLS Laboratory Directors or Managers, we can implement
strategies to guide test ordering but are often met with resistance due to our perceived lack of standing in the medical community. We needed the doctoral degree to stand out and stand at the head of the table to be recognized for our knowledge and impact. I strongly believe this will not cause infighting. Much like the collaboration that occurred in 2009 between ASCLS’s National Credentialing Agency (NCA) and ASCP’s Board of Registry (BOR) to develop what is now the ASCP Board of Certification, these two great organizations are focused on how laboratory medicine contributes to quality patient care and the excellence of credentialed professionals in our industry. Work is underway for a credentialing exam to bring recognition to the DCLS as a new certification.
How do you think the relationship works between proper dressing, personal comportment, and patient care?
I use this title as you have highlighted key qualities of professionalism. I will be transparent and tell you that I had to look up the word “comportment” which means “behavior” or how one “carries themselves.” Thank you! I love extending my vocabulary AND you hit the nail on the head! We can all go to MLT, MLS, or Phlebotomy school and most of us will do well and pass our certification exams, but what is the secret sauce for those who truly succeed and those who struggle? It is how they build trust in relationships. In healthcare, the most important trusting relationship you can build is with the patient. I often tell my phlebotomy friends that they are the most important part of the laboratory team. First, it is their quality sample that produces a quality result. The best scientist and chemistry analyzer cannot “fix” hemolysis. Second, it is the phlebotomist that is interacting directly with the patient. There have been multiple studies done on the link between positive patient outcomes and the level of trust patients feel with their healthcare providers. One such example is AIDET, which is a communication tool developed by the Studer Group to enhance interactions between healthcare professionals and patients. AIDET is an acronym that stands for Acknowledge, Introduce, Duration, Explanation, and Thank you.1 This is what a phlebotomist does every time they enter a patient room, and it builds trust when all healthcare professionals follow the same guidelines.
A non-verbal communication tool that builds trust is proper attire. Most hospitals will have a dress code or certain color of scrubs that distinguishes one department from another so that patients can easily identify which professional has entered their room to provide care. This helps reduce anxiety and build familiarity with the healthcare team. How you dress and your professional appearance builds trust.
Finally, a patient is always watching the interactions of their team and how they work together to provide them with care. If a doctor is unkind to a nurse or a nurse is unkind to a phlebotomist in front of a patient, do you think this builds trust or destroys the trust a patient might have regarding the care they are receiving?
A team member’s behavior outside patient areas also


The smarter diagnostic solution for bloodstream infections
Critical results to guide life-saving treatment decisions in the fight against sepsis and antimicrobial resistance1
The LIAISON PLEX® Bloodstream Infection Portfolio features three FDA-cleared multiplex molecular assays, offering comprehensive pathogen detection for 48 bacterial and fungal species associated with bloodstream infections and sepsis, and 12 clinically significant antimicrobial resistance markers, enabling rapid, targeted antimicrobial interventions to optimize patient care.
Designed for seamless laboratory workflow integration, the system minimizes unnecessary testing and enhances diagnostic accuracy. By supporting evidence-based decision-making, it advances antimicrobial stewardship initiatives and optimizes patient management outcomes.
1. Taryn A Eubank, et all , Role of Rapid Diagnostics in Diagnosis and Management of Patients With Sepsis, The Journal of Infectious Diseases, Volume 222, Issue Supplement_2, 15 August 2020, Pages S103–S109.






LIAISON PLEX® BSI
Optimize treatment in hours – not days.
LIAISON PLEX® Gram-Positive Blood Culture Assay
LIAISON PLEX® Gram-Negative Blood Culture Assay
LIAISON PLEX® Yeast Blood Culture Assay














































































matters. If you are working in the lab with a toxic co-worker who is rude, lazy, or displays unexpected verbal outbursts, this can be distracting and cause unnecessary stress. The nature of laboratory medicine can be stressful enough with the demands for exactness, quality, and timely reporting. It can become intolerable to work in a negative environment that goes unchecked by leadership. If you encounter inappropriate behaviors that affect team culture, please inform your supervisor so that expectations regarding conduct can be properly communicated. If it is your leader that is causing issues, then go to your human resource department with your concerns. No one wants to lose good team members due to a poor working environment when this can be addressed and improved.
Help! I hate my job, what do I do?
DEAR DESPERATE:
You haven’t given me a lot to work with but I can tell you that no one should be miserable day in and day out in their job. Medical Laboratory Science is a meaningful, important, and fantastic profession that provides many opportunities. Is it the culture? Talk to your supervisor on how your environment is impacting your ability to enjoy your work. Is it the type of work? Maybe you would excel in Microbiology where testing is more “hands on” than with the instrument automation in Chemistry. Is it the pay? Research your opportunities for shift differential or extra shifts that pay overtime. Is it staff interactions or leadership communication? Talk with other leaders in the organization — your boss’s boss or Human Resources. Make sure your core values match the organization you work for. Maybe for-profit healthcare is not your thing, maybe hospital work is too much, maybe you would like to sell or fix laboratory equipment. Join a professional organization, attend a meeting or two, network, and meet like-minded people who can recommend other opportunities. Or – you can always hire a coach!
What is the best way to get team members to speak up about their concerns or questions during a medium sized (10–15 people) collaborative interdepartmental meeting? I am leading a project where most people either keep their thoughts to themselves, or they send me a direct message right after the meeting to ask a question that would benefit the whole group.
There is a lack of trust between the members on this team. Since this is interdepartmental, perhaps there has been some miscommunication in the past or hard feelings between the departments that make it challenging to feel vulnerable. This is often a barrier to trust, the fear of speaking up and experiencing negative consequences. I don’t know how long your team has been meeting, but it is never too late to start talking about trust and what is getting in the way.
Most everyone hates team building exercises, especially anything that makes them get out of their chair, but there are some things that you can do to help people clear up any internal barriers that come with mistrust. 1) You can hand out sticky notes and have each person write down their negative thoughts. Then take a trash can and have each person tear up their sticky note and throw them away.You can describe how this is getting rid of the mucky muck that is interfering with
collaboration. 2) You can set an intention for each meeting: Provide an agenda that starts with a list of intentions.“For this meeting I am willing to be…. Appreciative, Attentive, Clear, Compassionate, Courageous, etc.” List at least 15–20 intentions. Have each member circle three and then go around the group and have each person read aloud their intentions. In my experiences, people start to share why they picked that intention for the meeting. The more people start to share, the more they get to know one another, and this opens the door for trust. 3) You can also set ground rules for each meeting. “What happens in Vegas, stays in Vegas.” No one should be oversharing outside of the group, undermining trust. If there are concerns about trust provided to you after the meeting, share that concern with the group anonymously so that it is out in the open and people can start having honest dialog about what is preventing trust within the group. If you want an example of a meeting agenda that includes intentions and ground rules, please email me for an example at patty@ thelableadercoach.com.
I live in an area with significant weather swings. This past winter was rough, and I got written up for missing too many days. I can’t believe they were so mean! Do they want me to die on the way to work?
DEAR SNOWBOARDER:
No, I am sure that your supervisors do not want you to die or even risk your life, which is why your facility probably had other options for you to “shelter in place” if there was a significant storm approaching. I, myself, have a blow-up mattress tucked under my desk for such occasions. Why? Because our patients need us and someone must be there to take care of them. Patients do not get to choose when they get sick or have health emergencies. As laboratory professionals, we are part of an elite healthcare team that have made a commitment to our patients regardless of the weather. Sure, we all get sick or miss a day now and then. Perhaps you tried your best to dig yourself out of the snow and was unsuccessful, but for you to get to the point where you were written up tells me that your absences are excessive as defined by policy. Your supervisor was not being mean. They are responsible for ensuring sufficient staff to provide quality testing. This is your wake-up call to see if you are really a good fit for healthcare. I believe it is a privilege to be a part of this meaningful and important work, but it demands a lot from us. If it means that your grandmother had a heart attack and I am there to run her troponin values so she can survive, it is all worth it. What do you think?
1. The AIDET® communication framework. Huronconsultinggroup.com. Accessed July 17, 2025. https://www.huronconsultinggroup.com/ insights/aidet-communication-framework.

Patty J. Eschliman, MHA, MLS(ASCP), DLM, CPC is a certified professional c oach who specializes in laboratory leadership growth and professional support. a s president and ceo of The Lab Leader Coach, patty coaches many lab professionals in all roles in the areas of building leadership skills, preventing burnout, improving communication, building cohesive teams, and how to be a positive influencer. She has 39 years of experience as a Medical l aboratory Scientist, the last 29 spent in leadership.



If a hospital performs one million tests per year and loses one in 1,400 tubes at a cost of $400–600 per tube, then the annual cost could be as much as $428K—not to mention the burden on patients and hospital.1
By implementing Indexor, you can trace samples starting at patient draw, monitor key quality indicators during transportation, and automate time-consuming lab operations.

By Robert F. Moran, PhD, FCCM, FIUPAC
Acid-base homeostasis, while resulting from complex interactions of biochemistry and physiology, boils down to lung and renal function/dysfunction responding to the rest of the body’s production of acids and bases in health and disease. Since the lungs are the first responders of the mammalian body, this is typically categorized as airway-based, tissue-based, or blood circulation–based. These are intimately linked to renal function, both leading to the measurements we refer to as ‘blood gases’ (pH, p O 2 and p CO 2)and related measurands.
The predominant specimen used for measuring pH, pO2 and pCO2 is from an arterial or arterialized capillary bed collection. Because of different susceptibility to collection errors, the specimen should be differentiated on the report using for example pH(aB) or pO2(caB) and should be collected using dry, soluble Li heparin (not therapeutic heparin) in the collection device. Measurements should be made within 10 minutes of collection rather than being placed on ice and batch tested.
Measuring the blood gases and pH
For pH alone and pCO2, the principle of measurement has changed little in the more than 50 years since John
Severinghaus and Greeman Bradley applied a silastic membrane to a pH electrode (and a cellophane membrane to a Clarck electrode) in the mid-1950s. The glass of a pH electrode integrates lithium into its silicate matrix separating a buffer and electronics from the blood specimen. As the hydrogen ion levels vary, the voltage across the glass changes, reflecting changes in pH. The silastic membrane on the CO2 electrode separates the blood from another buffer on the outside of a pH electrode so the
change in pH of that buffer represents only the changing pCO2. For oxygen, the cellophane membrane on the oxygen electrode separates the blood from a buffer in which a set voltage is applied forcing the stoichiometric conversion of oxygen to current. With calibration, these voltages/currents are converted to the appropriate values. The same concepts are used to measure other ions and molecules, (e.g., a pO2 electrode is at the heart of many glucose meters, both whole blood and continuous.
Figure 1 shows the essentials of the human homeostatic systems. Notably, the blood gases are of themselves only a small part. However, the primary measured gases are essentially linked to all, especially the acid-base (pH). Each gas is the driving force in the system.
The primitive base-to-acid ratio (~20:1) has not only survived inside many species but has become critical for the proper functioning of the whole organism. This is reflected in the role that hydrogen ion concentration plays in many metabolic systems including the extraction of energy from food, the maintenance of cell and tissue integrity and oxygen transport and delivery.
While in various texts, each system is typically discussed on an individual basis for the sake of conceptual understanding, they are all fundamentally related. For a comprehensive but brief overview, this author suggests the monograph by John Toffaletti, “Blood Gases and Electrolytes.”
The human body continually produces acid as it produces energy. Much of this acid is in the form of carbon dioxide (CO2), the end-product of aerobic metabolism which is akin to combustion — the burning metabolically of carbohydrates and related compounds resulting in CO2 and water. The CO2 is eliminated by the lungs at an approximate rate of almost 300 liters per day per human.
In addition to CO2, a typical ‘western’ mixed diet produces metabolic acids such as phosphoric and sulfuric acidsreferred to as “fixed” acids since they cannot be converted to CO2. Dietary bases produced metabolically neutralize some of the acids, but the rest must be neutralized by the body so that acid-base homeostasis is maintained.
Acids produced as a part of aerobic metabolism are, in general, either carbonic acid (resulting from the direct metabolism of carbohydrates) or ketoacids (acetoacetate, hydroxybutyrate). The carbonic acid results from dissociation of the dissolved CO2 into its components. Ketoacids, however, dissociate directly into hydrogen ions (H+) and the corresponding anions. The result is the dynamic equilibrium between the various anions and the hydrogen ions. The sources of specific H+ are indistinguishable, and the H+ status can usually be assessed by an understanding of the carbonic acid/bicarbonate system alone.
<7.30/> 44
<30.0/4.0
30-50/4.0-6.7
>50/6.7
7.30-7.50/44-31.6
<30.0/4.0
30-50/4.0-6.7
>50/6.7
> 7.50/<31.6
<30.0/4.0
30-50/4.0-6.7
>50/6.7
Metabolic acidosis, partial compensation
Metabolic acidosis
Ventilatory insufficiency/Failure-acute
chronic alveolar hyperventilation
Acceptable acid-base
Ventilatory insufficiency/Failure-chronic
acute alveolar hyperventilation, alkalosis
Metabolic alkalosis
Metabolic alkalosis, partial compensation
Acid-Base Balance Dysfunction: Respiratory Etiology
Acidosis: (Hypoventilation) Alkalosis: (Hyperventilation)
• airway obstruction: Foreign Body, pneumonia, emphysema, etc.
• cNs depression: Narcotics, anesthetics, injury, tumor
• thoracic injury: Pneumothorax, flail, chest, tracheal tear
• Mechanical ventilation: inadequate rate and/or tidal volume, etc
• chest wall disease (Musculoskeletal and Neuromuscular dysfunction)
• Miscellaneous: congestive heart failure severe obesity.
• cNs disorders: injury, stroke, anxiety
• Hypoxia: ards, pulmonary emboli,atelectasis, anemia (low hemoglobin)
• cNs depression: Narcotics,
• Mechanical ventilation: excess tidal volume and/or rate
• Hypermetabolism: Fever, sepsis
• Miscellaneous: congestive heart failure, salicylate intoxication,cirrhosis
• apprehensive about potential pain caused by arterial puncture.
• excess mechanical ventilation.
Acidosis: Alkalosis:
• diarrhea, small bowel fistula, ureterosigmoidostomy (co2 loss)
• Proximal & distal renal tubular acidosis
• acid administration (Hcl, NH4cl)
• ‘dilutional’ acidosis (volume from Hco3 free fluids)
• With elevated anion Gap (anGap)
• diabetic ketoacidosis
• lactic acidosis (anaerobic metabolism)
• o2 availability decrease, e.g., after vigorous exercise.
• any condition impairing o2 delivery
• Uremia and some poisons
• combination of fixed acid loss, base gain, or potassium depletion.
• Bicarbonate/carbonic acid ratio
• Pulmonary compensation–decreased rate/depth of ventilation
• incomplete/insufficient compensation (drive to supply o2 takes precedence over a-B balance)
• renal compensation is the same if renal is not involved in the primary cause
• excretion of Hco3, retention of acid salt, and decreased NH4+
• Bicarbonate administration
• excess amounts of otc antacids
Table 3. acid-base balance: ‘Metabolic’ (non-pulmonary) conditions.
Hydrogen ions produced by metabolic action will cause a decrease in blood pH if “buffering” systems are not in place and functioning. Because changes in pH in either direction can alter the H+ impact on enzyme-catalyzed equilibria, various enzyme systems can be significantly affected. Additionally, the dynamic equilibria set up between hemoglobin and oxygen is also influenced by pH. Further, in situations involving tissue hypoxia, more acid is produced (e.g., lactic acid), putting the organism at a further disadvantage (e.g., multiple organ failure).
With these several examples in mind, all of which can be occurring in any one patient, it is simple to see just how critical the understanding and assessment of acid-base status is to the physician and the laboratorian both.
Buffers are used by the human body to support the hydrogen ion levels/pH within a necessary range for effective functioning of the many metabolic processes. The pulmonary and renal organ systems are two organs that ‘buffer’ changes in pH. However, neither are chemical buffers. Chemical buffers are substances that minimize changes in the pH of a solution when strong acids or bases are added. A major biologically important chemical buffer is the carbonic acid/bicarbonate pair, not only because it is quantitatively the largest at more than 50% of the total, but also because the bicarbonate system is integrally related to the pulmonary and renal systems, and it can be readily measured in the blood.
Chemical buffers present in the tissues/fluids react at once to neutralize any acid produced. However, two secondary mechanisms for “buffering” are significant — the fast-acting pulmonary system, (minutes to hours), and the renal system (hours to days). Their actions are summarized in Figure 2
When the carbon dioxide produced in tissues during metabolism dissolves in the aqueous intra/extra cellular fluids and by diffusion dissolves in the blood, it forms an equilibrium according to the basic chemical Law of Mass Action as shown in Figure 2. The amount of carbonic acid formed equals the product of the solubility and unit conversion constant KS, and the partial pressure of the carbon dioxide gas produced.
co2 + H20 → H2co3 cH2co3* = K5 • Pco2
Ks = 0.307 (Bunsen soubility)
H2co3, H++ Hco3- c H* = K3 • H2co3 Hco3renal Pulmonary
Henderson-Hasselbalch: (Negative logarithm of equation))
* the lower case italic ‘c’ used above is the designated symbol indicating the molar concentration of the entity represented by the chemical symbol that follows.
K3 = Mass action (acid)
Ventilation Variable: PCO2
renal Variable: HCO3*
pH = pKa + log10 salt acid pH ∝ log10 Hco3H2co3 20 1 =
As may be seen in Figure 2 , the Henderson-Hasselbalch relationship enables the evaluation of the acid-base data (pH) from a blood gas report with respect to both primary acid-base disorder and compensating responses.
The amount of hydrogen ion (measured pH) in the blood is key to the interpretation of a blood gas report since it answers the basic question of if the condition is acidosis or alkalosis. Changes in the measured pCO2 leading to changes in pH come next. Increases in pCO2 result from hypoventilation with a later increase in carbonic acid and hydrogen ions (decrease in pH). Thus, a decrease in pH due to an increase in pCO2 (hypoventilation), is classified as a pulmonary or respiratory acidosis. The reverse, a decrease in pCO2 due to hyperventilation, results in a pulmonary or respiratory alkalosis because of the decreased carbonic acid and later increase in pH.
Table 1 summarizes acid-base status based on the measured values from a blood gas system—the quantities known with greatest certainty — pH and pCO2, rather than values for other quantities such as base excess, which arise from assumptions and calculations. A caveat regarding Table 1: Medically, ventilatory failure implies decreased ventilation, which causes increased CO 2 and H ions and decreased pH. If the respiratory system is responding to metabolic
Chemical Strength: pKa = 6.105
Physiologic Strength: salt/acid ratio
acidosis by trying to blow off CO2, it will never blow off enough to normalize pH above 7.4 assuming a simple blood gas disorder. If there were a second coexisting abnormality (double gas disorder) then the pH could increase above 7.4. Some of the clinical implications of the acid-base disorders are shown in Tables 2 and 3. The important thing to recall is the broad-based application of acid-base status; as to a great extent, that status reflects many serious conditions but is not typically a diagnosis in itself. See the October issue for part two of this two-part series for a discussion of the final measurand-oxygen.
1. Toffaletti JG. Blood Gases and Electrolytes 2nd ed. American Association for Clinical Chemistry; 2009.
2. Moran RF, Liesching TN. The ABC’s of Abg’s(Tm): A Cyclopedic Dictionary of the Testing Terms Used in Critical Care. Momentum Press; 2018.

Robert F. Moran, PhD, FCCM, FIUPAC is the Principal scientist at mviSciences , a consulting and educational services organization and President of accutest™ Proficiency testing s ervices. dr. Moran served multiple terms on the N ccls (Now clsi) Board of directors and was an active participant or chairholder in several of their blood gas and electrolyte standards-writing teams. a lso active in clinical chemistry internationally, he is an appointed Fellow of the international Union of Pure and a pplied c hemistry (F iUPac). He is a retired professor of chemistry and physics from Wentworth institute of technology but remains active in consulting work and writing.

The NEW GEM Premier 7000* with iQM3 is the first and only blood gas system to provide lab-quality hemolysis detection right at the point of care. 2 Hemolysis elevates potassium by up to 152%—tackle the #1 preanalytical error and elevate patient care.3–5























Express Hemolysis Detection
Blood gas results with hemolysis detection in 45 seconds at the point of care, which may reduce the need to send samples to the lab for recheck, saving blood and time.6
Effective and efficient
Whole blood hemolysis detection can help reduce unnecessary sample collection, delays, and inappropriate treatment. Ultimately, it can help optimize staff time, reduce costs, and improve patient management.
Track-to-Train
Go beyond detection. Lower preanalytical error rates due to hemolysis with GEMweb® Plus 500 Custom Connectivity by tracking operators and locations to identify where further training is required. Plus, Werfen Academy can provide the necessary content for instruction.
References 1. Lippi G, Salvagno GL, Favaloro EJ, Guidi GC. Survey on the prevalence of hemolytic specimens in an academic hospital according to collection facility: opportunities for quality improvement. Clin Chem Lab Med. 2009;47(5):616–618. doi:10.1515/CCLM.2009.132. 2. Balasubramanian S, McDowell EJ, Laryea ET, et al. Novel in-line hemolysis detection on a blood gas analyzer and impact on whole blood potassium results. Clin Chem. 2024;70(12):1485-1493. doi:10.1093/clinchem/hvae135. 3. Lippi G, Fontana R, Avanzini P, Sandei F, Ippolito L. Influence of spurious hemolysis on blood gas analysis. Clin Chem Lab Med. 2013;51(8):1651–1654. doi:10.1515/cclm-2012-0802. 4. Lippi G, von Meyer A, Cadamuro J, Simundic A-M. Blood sample quality. Diagnosis. 2018;6(1):25–31. doi:10.1515/dx-2018-0018. 5. O’Hara M, Wheatley EG, Kazmierczak SC. The impact of undetected in vitro hemolysis or sample contamination on patient care and outcomes in point-of-care testing: a retrospective study. J Appl Lab Med. 2020;5(2):332–341. doi:10.1093/jalm/jfz020. 6. Werfen. GEM Premier 7000 with iQM3 Operators Manual. P/N 00000026407. Rev 00. Aug 2023. 7. Phelan MP, Hustey FM, Good DM, Reineks EZ. Seeing red: blood sample hemolysis is associated with prolonged emergency department throughput. J Appl Lab Med. 2020;5(4):732–737. doi:10.1093/jalm/jfaa073. 8. Wilson M, Adelman S, Maitre JB, et al. Accuracy of hemolyzed potassium levels in the emergency department. West J Emerg Med. 2020;21(6):272–275. doi:10.5811/westjem.2020.8.46812. 9. Milutinović D, Andrijević I, Ličina M, Andrijević L. Confidence level in venipuncture and knowledge on causes of in vitro hemolysis among healthcare professionals. Biochem Med. 2015;25(3):401–409. doi:10.11613/BM.2015.040. 10. Phelan MP, Ramos C, Walker LE, et al. The hidden cost of hemolyzed blood samples in the emergency department. J Appl Lab Med. 2021;6(6):1607–1610. doi:10.1093/jalm/jfab035.


By Allyson J. Kozak, PhD, MBA, NRCC
Laboratorians have long recognized the unmatched clinical value of mass spectrometry (mass spec)—the diagnostic marvel well known for exceptional sensitivity, specificity, and accuracy. And while mass spec has been a fixture in forensic and reference laboratories for decades, this powerful, yet highly complex testing technology has been grossly underutilized due to operational barriers preventing seamless integration into the routine core clinical chemistry laboratory. In addressing this critically unmet need, emerging technology is on the horizon. The rise in automation of mass spectrometry is overcoming what was once an insurmountable challenge, clearing a path for more widespread, routine use of mass spec in clinical diagnostics.
An analytical technique that measures the mass-to-charge ratio (m/z) of molecules such as peptides, proteins, and drug metabolites, mass spec helps identify and quantify compounds, as well as evaluate their molecular structure and chemical composition, with better specificity and sensitivity than other methods.1 Historically a manual testing process requiring highly trained lab personnel, mass spec is often considered the gold standard in vitamin D testing, steroid hormone measurement, and immunosuppressive and therapeutic drug
monitoring. Its unique ability to analyze small molecules at very low concentrations delivers an unparalleled level of detail to understand the underlying mechanisms of disease and a human body’s reaction to medication. Additionally, mass spec has less cross-reactivities and significantly fewer matrix effects and interferences than other detection methods. It is highly beneficial in improving the sensitivity of disease screening, therapeutic drug monitoring, and diagnostic testing.
Automated mass spec has the potential to revolutionize the way clinical mass spectrometry is used to enable better patient care, and ultimately, deliver the best possible outcomes for patients. With automation, more labs will benefit from precision mass spec testing in routine clinical practice, resulting in trickle-down advantages for healthcare systems and, of course, patients who stand to benefit the most.
Years of research and discovery in the making, mass spec automation is rooted in the development of paramagnetic particles, a chemistry technology used in the sample preparation step to separate the element to be analyzed from the

Dipper POCT Urinalysis Dipstick Control is a revolutionary, single-use liquid urinalysis control with a 3-year refrigerated stability from the date of manufacture. ®
The only liquid urinalysis control that is stable at room temperature for 90 days, allowing you to take it where you need it most, freeing up refrigerator space.






Peel. Toss. Dip.
*Urinalysis dipsticks not included














rest of the patient sample. From there, automating the entire mass spec workflow involves numerous innovations in chemistry, biology, bioinformatics, and hardware development, all working in tandem to simplify mass spec’s sample-toresult interpretation process. The outcome is a user-friendly automated process that seamlessly integrates with the lab’s existing operations and requires no specialized training.
Future mass spec automation will create countless benefits for today’s laboratories. Amid continuing laboratory staffing shortages, labs are expected to manage increasingly high numbers of samples at a faster pace, while retaining quality, delivering value, and improving cost efficiency. For labs facing these and other industry challenges, mass spec automation means simpler workflows that allow for more walk-away time, higher productivity, and increased efficiencies.
Other major advantages of mass spec
Improvement in throughput and turnaround time (TAT)
With automation, mass spec can be completed without batching samples, cutting TAT from days to hours, in some cases. Running samples in random access will allow labs to offer 24/7 and STAT sample testing. Automation will also eliminate the need for lab specialists to process samples. Automating these processes could improve TATs and throughput by more than 25%.2
High-quality, standardized results
Lack of standardization is a major challenge in mass spec today. Labs are often faced with numerous instrument configurations, as well as varying pre-analytic and analytical methods, data acquisition conditions, calibration and quality control concepts, and methods to interpret results. This can make it very difficult to compare results between labs and even between instruments within the same lab.3,4 Standardization of these parameters is extremely important for establishing and using reference ranges, and for the longitudinal measurements that are needed for patients who, for example, require lifelong therapeutic drug monitoring following solid organ transplantation. The availability of commercial mass specbased assays that are anchored to reference measurement procedures and reference materials will allow for accurate and precise test results independent of time, patient, and location.
While the benefits of automated mass spec start in the lab, there are a host of advantages for healthcare systems and the patients they serve. With significantly shorter TATs, physicians can diagnose disease faster and with more precision—a huge plus for high-acuity clinical units and intensive care. Even the clinical labs that offer mass spec today batch test and aren’t operationally equipped to run 24/7 mass spec testing. In rural areas without local access to reference labs, the need for on-site mass spec is even greater. In fact, considering the typical TATs of five or more days, many rural providers opt out of sending samples for testing because their patients can’t afford to wait that long for treatment. Rapid on-site mass spec testing will reveal a better clinical picture, supporting providers in treatment decisions. Healthcare systems will achieve greater efficiencies and be better positioned to manage patient care with a mass spec process that is automated, standardized, and integrated.
As with all diagnostic testing, mass spectrometry’s greatest asset is its ability to improve patient care and deliver better
health outcomes. To that end, automated mass spec supports timely and accurate diagnosis and may, in many cases, allow for earlier diagnosis of cancer and chronic diseases. Routine mass spec testing—more easily enabled through automation— is highly beneficial for certain patient groups. The technology adds value in treating patients with hormone receptive breast and prostate cancer, those with vitamin D deficiencies, organ transplant recipients, and patients undergoing therapy for tuberculosis.
Antibiotic dosing with therapeutic effect is often difficult to achieve, especially in critically ill patients, and is yet another clinical arena in which automated mass spec can add value. Through accurate and precise drug monitoring, automated
As with all diagnostic testing, mass spectrometry’s greatest asset is its ability to improve patient care and deliver better health outcomes.
mass spec can reveal whether therapeutic concentration is reached and help determine if adjustments need to be made. This not only improves the likelihood of therapeutic success (while decreasing the risk of drug-related adverse events), but also helps limit the emergence of drug-resistant bacteria. With the advent of automated mass spectrometry, laboratories are at the forefront of a paradigm shift in how this high-value diagnostic technique can be used to deliver better patient care. Automation will make routine mass spec testing possible, while enhancing lab workflows and addressing key operational and staffing challenges. The wider availability and more routine use of this technology will enable healthcare systems to provide better decision-making support for clinicians. As the future of laboratory medicine, automated mass spec provides sustainable, accessible solutions to tackle the healthcare challenges of tomorrow.
1. Smith RW. Mass Spectrometry. In: Encyclopedia of Forensic Sciences Elsevier; 2013:603-608.
2. Jannetto P. Eliminating the disconnect between people and processes. Clinical Laboratory News. Published November 1, 2015. Accessed July 18, 2025. https://myadlm.org/cln/articles/2015/november/ automating-sample-preparation-for-mass-spectrometry.
3. Vogeser M, Schuster C, Rockwood AL. A proposal to standardize the description of LC-MS-based measurement methods in laboratory medicine. Clin Mass Spectrom. 2019;13:36-38. doi:10.1016/j. clinms.2019.04.003.
4. Seger C, Kessler A, Taibon J. Establishing metrological traceability for small molecule measurands in laboratory medicine. Clin Chem Lab Med. 2023;61(11):1890-1901. doi:10.1515/cclm-2022-0995.

Allyson J. Kozak, PhD, MBA, NRCC is a scientific liaison in Medical and scientific a ffairs, a non-commercial division of Roche Diagnostics she cultivates scientific relationships to shape medical strategy and improve patient care delivery. Before joining roche, Dr. Kozak was the laboratory medical director for MetroHealth in cleveland, ohio, where she oversaw various testing areas and served as the toxicology expert witness for cuyahoga c ounty. she was also an assistant professor at case Western reserve university school of Medicine. in addition to a bachelor’s degree in chemistry from the c ollege of Wooster, Dr. Kozak holds a phD in analytical chemistry and an MB a in finance from ohio university.
Sebia is the only provider delivering a complete solution for multiple myeloma and light chain amyloidosis (AL amyloidosis) - supporting screening, diagnosis, and monitoring, now with the addition of serum free light chain testing.





















































This new 3-Screen ELISA allows for the simultaneous detection and measurement of autoantibodies to GAD and/or IA-2 and/or ZnT8 in a simple, highly-robust, user-friendly assay format.



To obtain additional information regarding this new product, together with KRONUS’ complete offering of immunoassay test kits, please call us toll-free at 800 4 KRONUS, email us at kronus@kronus.com or scan the qr code below.








t he tosoh G8 a nalyzer utilizes the ion- e xchange HPL c method of Hb a1c measurement with less than 2% c Vs. tosoh G8 is suitable for high throughput Hb a1c testing in the laboratory or clinic environment. t he compact analyzer detects and presumptively identifies commonly occurring hemoglobin variants.
Tosoh Bioscience
t he K ro N us 3- s creen islet c ell a utoantibody e L isa a ssay Kit is for the simultaneous detection of autoantibodies to G ad and/ or ia -2 and/or Znt 8 in human serum. a bsorbance is measured and is proportional to the total amount of autoantibodies present. For r esearch u se o nly. Not For u se in diagnostic Procedures.
KRONUS

total solution for hospital blood glucose
Hospital blood glucose technology has advanced, empowering healthcare providers with fast, reliable results and efficiency. t he accu- c hek inform ii system is a wireless hospital b GM with patented test strip technology and easy-to-use lancing devices, all backed by 24/7 technical support.
Roche










Three markers. One powerful panel. GSP | 1,5-AG | HbA1c
Diazyme offers a suite of diabetes assays designed to provide multiple perspectives on glycemic status:
Glycated Serum Protein (GSP) Reflects average blood glucose over the past 1–3 weeks.

1,5-Anhydroglucitol (1,5-AG)
May be useful in assessing short-term glycemic fluctuations.
Hemoglobin A1c (HbA1c) Reflects average blood glucose over the past 2–3 months.

Discover the full story behind every patient’s glucose levels. Ask us how Diazyme’s Diabetes Panel can support better monitoring and management today.
FDA-cleared assays | Clinical relevance across diverse populations | Compatible with most open clinical chemistry platforms
Contact Diazyme today to request a quote or learn more. www.diazyme.com/diabetic-markers | sales@diazyme.com | +1-858-455-4588 Diazyme Laboratories, Inc. – Advancing Clinical Diagnostics Worldwide


Nova’s Next Generation s tat s trip Glucose Hospital Meter s ystem, the only meter F da -cleared for use with all critically ill patient samples, includes features that make hospital glucose testing easier and cybersecure while retaining the accuracy and freedom from interferences s tat s trip has provided for over a decade. Features include a Linux os , wireless charging, r F id /NF c data entry, sealed battery casing, hematocrit range 5% - 75%, and rugged external meter casing.
Nova Biomedical
c ontrol LQ Hb a1c (order Number: K067M-8) is intended to simulate human patient whole blood samples for the purpose of monitoring the precision of laboratory testing procedures for the following assays: Glycohemoglobin a1c.
Audit MicroControls


ada M s H a -8180 is an automated hemoglobin a1c analyzer with diagnosis claims employs gold standard HPL c technology. t he analyzer generates quality results and provides high-level precision to accurately report Hb a1c and aid physicians with:
• diagnosing diabetes
• identifying patients at increasing risk for diabetes
• Monitoring blood glucose control
Arkay

acusera diabetes Q c ’s offer a true third-party solution for diabetes and haemoglobin variant testing, compatible with multiple platforms. With up to four weeks’ reconstituted stability, waste and costs are significantly reduced. benefit from less preparation time without compromising consistency or quality, with acusera.
Randox
Fully Automated A1c Testing. Load racks and walk away.
More than A1c: One Platform, Multiple Assays. Consolidate HbA1c, Hb, and Myeloma testing.
Unmatched Resolution: Clearer Results, Superior Hb Variant Detection. Easy-to-interpret patterns when Hb variants are present.
Built-in Safeguards for Smart Reporting. Provide confidence in results and better patient care.




Hardy Diagnostics releases FDAcleared NG-TEST® CTX-M Multi in the United States. CTX-M Multi is an in vitro, rapid, and visual immunoassay for the qualitative detection of CTX-M enzymes (groups 1, 2, 8, 9, and 25) for the rapid detection of ESBL’s.
CTX-M-mediated ESBL-producing bacteria, primarily Escherichia coli, have been identified in various settings, including hospitals and long-term care facilities. While initially thought rate, CTX-M enzymes are now recognized as a significant cause of extended-spectrum cephalosporin resistance.
Using CTX-M Multi provides detection in just 15 minutes from isolated colonies.




